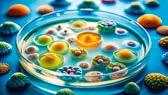

Das neue CLE Coupé: Shaped by desire.
Im neuen CLE Coupé wird jede Reise zum erstklassigen KomfortErlebnis – dank einer Vielzahl an Ausstattungen für Ihr Wohlbefinden
JETZT BEI UNS ERLEBEN.

![]()

Das neue CLE Coupé: Shaped by desire.
Im neuen CLE Coupé wird jede Reise zum erstklassigen KomfortErlebnis – dank einer Vielzahl an Ausstattungen für Ihr Wohlbefinden
JETZT BEI UNS ERLEBEN.



Gesunde und nachhaltige Ernährung kann so einfach sein!
In einschlägigen Medien hört man immer wieder komplizierte Ernährungsempfehlungen, die den ein oder anderen möglicherweise davor zurückschrecken lassen, sich mit gesunder und nachhaltiger Ernährung zu befassen. Oft hört man hier das Argument: „Gesunde Ernährung kann ich mir doch gar nicht leisten“. Aber weit gefehlt!
Gesunde Ernährung bedeutet (auf das Minimale runter gebrochen): viel Gemüse (und Obst), Vollkorngetreideprodukte, Hülsenfrüchte sowie Nüsse und pflanzliche Öle, die wichtige ungesättigte Fettsäuren und Vitamin E
Grundsätzlich sollte der Verzehr von pflanzlichen Lebensmitteln im Verhältnis zu tierischen Lebensmitteln gesteigert werden. So können Sie Gesundheit und Umwelt zugleich schützen. Der teure Fleischkonsum und Konsum verarbeiteter Lebensmittel darf also gerne in größeren Mengen unterbleiben, wenn man die pflanzlich basierten Eiweißquellen gut kennt und geschmacklich lieben lernt. So sind Hülsenfrüchte beispielsweise ein wichtiger Eiweißlieferant im Verbund mit komplexen Kohlenhydranten, die ballaststoffreich und günstig im Einzelhandel viel zu selten gewählt
Auf teure Vitaminpräparate sollte man nur bei nachgewiesenem Mangel auf ärztliche Anordnung zurückgreifen. Auch das schont den Geldbeutel und schafft Ressourcen für Geldaufwendung für frisches Gemüse und Vollkornprodukte.
Bleiben Sie also motiviert und versuchen Sie, diese einfachen Empfehlungen in Ihren Alltag zu integrieren. Ihr Körper und unsere Erde werden es Ihnen danken.
Viel Freude bei der Lektüre dieser Ausgabe von GLEIS EINS wünscht Ihnen
Dr. med. Inga-Nadine Kummer
Fachärztin für Innere Medizin, Diabetologin DDG/LÄK, Notfallmedizin, Ernährungsmedizinerin DGEM/DAEM und Adiposiologin DAG-DDG (Praxisporträt Fachinternisten Aschaffenburg Seite 40 – 41)
GLEIS EINS – Zentrum für Ambulante Medizin | Aschaffenburg
Herausgeber: sl-werbung GmbH · Stephan Lehmann · Gutwerkstraße 18 · 63743 Aschaffenburg /5 50 57 99 E-Mail s.lehmann@sl-werbung.com (für die inhaltliche Richtigkeit der Anzeigen und medizinischen Beiträge in den Anzeigen sind die Vertragspartner und nicht der Herausgeber verantwortlich) Iris Solbès (Fragen/Anmerkungen an die Redaktion: E-Mail s.lehmann@sl-werbung.com)
Fotonachweise: S. 8 Vielfalt21, S. 9 Giordano Aita, S. 10 maestro, S. 12 Plson, S. 16 Joyce, S. 18 MAn888 und prapatsorn, S. 19 MAn888, S. 20 Racle Fotodesign, S. 22 Avr Di, S. 24 Arnada, S. 26 nenetus, S. 28 Background_Studio, S. 30 Sementsova321, Q und Alexander Raths, S. 32 Thanawat, S. 34 raja, S. 39 Plaifah, S. 42 anzodesign, S. 44 Daniel Vinceh, S. 46 fotogurmespb, S. 48 Sahaidachnyi Roman, S. 49 Misses Jones (alle Adobe Stock), S. 4 otticcreative, S. 6 CDD20 (beide pixabay), Johannes Heeg, Petra Reith, DJäger, Dirk Nitschke, Susanne von Mach und Thomas Hesse Kuthal print&binding GmbH · Johann-Dahlem-Str. 54 · 63814 Mainaschaff
Titelthema
Gesunde Ernährung: Sprechen Sie paleo-flexitarisch? 4-8
Gesundheitsvorsorge
Ihr ganz persönlicher
Gesundheits-Check-up! 9-13
Medizinische Einrichtungen
Sprachtherapie
Kinder: Sprachentwicklungsstörung 16
Augenoptik & Hörakustik
PRIME HEARING
So klingt Hörvergnügen inklusive. 17 Urologie
Die Urinuntersuchung: Eine kleine Probe mit großer Aussagekraft 18-19
Frauenheilkunde
Gesunde Ernährung in den Wechseljahren: Schlüssel zu Wohlbefinden und Lebensqualität 20-21
Kardiologie und Innere Medizin
Mehr als nur ein Trend: Herzgesunde Ernährung à la Mittelmeer 22-23
Physiotherapie/Fitness/ Kosmetik & Fußpflege
Physiotherapie: Ernährung als Grundlage für Regeneration und Muskelaufbau 24-25
Apotheke
Zeit für eine Ernährungswende 26-27
Gastroenterologie und Innere Medizin Ernährung und Fettleber –ein direkter Zusammenhang 28-29
Sprachtherapie
Warum immer mehr Kinder kieferorthopädische & logopädische Behandlungen benötigen 30-31
Augenheilkunde
Makuladegeneration: Gesunde Ernährung bringt mehr als Nahrungsergänzungsmittel 32-33
Zahnmedizin
Beauty-Trend für die Zähne: Gesunde Ernährung 34-35
Orthopädie und Sportmedizin Zusammenhang von Knie- und Sprunggelenkschmerzen bei Fußproblemen 36-37
Radiologie und Nuklearmedizin Digitale Innovation in der Patientenkommunikation: BAG Radiologie & Nuklearmedizin Aschaffenburg 38-39 Innere Medizin Lernen mit Diabetes gut zu Leben. 40-41
Kieferorthopädie
Gesunde Ernährung und gerade Zähne: Der Schlüssel zu Wohlbefinden und Jugendlichkeit 42-43
Neurologie
Gesunde Ernährung bei Autoimmunerkrankungen 44-46
News & Intern
Frauenärzte Gesundheitszentrum
Aschaffenburg: NEU im Team –Frau Tâmara Camargos Jensen 47 Im Gespräch
Frau Veronika Köberlein
(Fachinternisten Aschaffenburg) Pflanzenbasierte Ernährung: Nachhaltige Wahl für Gesundheit und Umwelt. 48-49
Info Im Notfall zählt jede Sekunde! 14-15 Wieder zwei neue AED Defibrillatoren von hubrich medical 50-51
Kultur
MAIN ART: Kulturelle Vielfalt im Herzen Aschaffenburgs 52-53
Überblick
Hier finden Sie uns 54-55
Verloren im Dschungel der Ernährungstrends?
Kein Problem, GLEIS EINS hat die Lösung.

Neulich beim Grillen: Horst haut sich mit glänzenden Augen ein 28 Tage gereiftes Monstersteak auf den Rost. Tochter Ida schreit: „Mörder!“, seine Frau schüttelt den Kopf über so viel ungesundes Fleisch und packt mit gebührendem Abstand ein Sojaschnitzel daneben. Gleichzeitig diskutieren alle, ob die Möhre besser mit auf den Grill sollte oder gleich roh geknabbert. Die Möhre sei eh nicht Ketogeeignet murrt Sohn Tom, er bevorzugt das Steak mit Mayo und am besten roh. Während Ida lautstark reklamiert, so werde es mit der Rettung der Welt wohl nichts, brummt Onkel Michael, vor 16 Uhr esse er heute gar nicht, er sei beim Intervallfasten. Nach 18 Uhr geht aber auch nicht, Oma Inge ist grad am Abnehmen und lässt die Abendmahlzeit weg. Verschämt packe ich meinen mangels Zeit mit
Gemüse aufgehübschten Premium-Nudelsalat vom Discounter meines Vertrauens unauffällig in die Ecke. Kohlehydrate sind böse und die ganzen leckeren Geschmacksverstärker auch.
Übertrieben? Ja, klar. Aber in einer Welt, in der Ernährungstrends genauso schnell kommen und gehen wie die neuesten Fitness-Gadgets, ist es nicht immer einfach, den Überblick zu behalten. Ob Keto, Paleo oder vegan, jede Diät und Ernährungsform hat ihre eigene Fanbase. Doch was sagt die Wissenschaft dazu? Und: wäre es nicht besser, das ganze etwas lockerer anzugehen?.
Wer in den letzten Jahren ein Auge auf die Ernährungstrends geworfen hat, wird festgestellt haben, dass es viele „Hypes“ gibt, die als das neue Wundermittel zur Gesundheit präsentiert werden. Doch wie viel ist dran? Schauen wir uns ein paar Trends doch einmal aus der Nähe an.
So können Sie uns erreichen:


AB-Immobilien Staab ist seit über 60-Jahren ihr zuverlässiger Partner für Bewertung, Verkauf, Vermietung und Verwaltung in Ascha enburg, Alzenau und dem Rhein-Main-Gebiet.
✔ Bewertung als Basis für Ihren Verkaufserfolg Unsere Sachverständigen erstellen objektive und unabhängige Bewertungen, unter Berücksichtigung von Art, Größe, Ausstattung, Bescha enheit und Lage.


✔ Strategie und der Weg zum Ziel
Jede Immobilie ist anders – jedes Verkaufsziel ist anders! Nur ein fester Plan führt in angemessener Vermarktungszeit zu Ihrem gewünschten Verkaufsziel.
✔ Marktveränderungen fest im Blick Bauweise, Renovierungsstand und Gebäudeenergie sind wesentliche Kernfragen der Käufergruppen. Unsere Immobilienkau eute kennen die hohen Anforderungen der Käufer.
Die ketogene Diät (kurz Keto) hat in den letzten Jahren einen enormen Popularitätsschub erfahren. Sie setzt auf eine drastische Reduzierung von Kohlenhydraten und eine Erhöhung des Fettanteils, um den Körper in einen Zustand der Ketose zu versetzen. In diesem Zustand beginnt der Körper, Fett statt Zucker als primäre Energiequelle zu nutzen.
Die Wissenschaft: Es gibt Hinweise darauf, dass Keto bei der Gewichtsreduktion und in der Behandlung von Epilepsie hilfreich sein kann. Aber es gibt auch Bedenken hinsichtlich der Langzeitwirkungen, insbesondere bei der Belastung des HerzKreislaufsystems durch den hohen Fettanteil. Eine ausgewogene Ernährung mit moderaten Kohlenhydraten bleibt für die meisten Menschen die bessere Wahl.
Wie es sich anfühlt: Wenn man sich den täglichen Speiseplan von Keto anschaut, fühlt es sich ein bisschen an, als würde man in einer Metzgerei arbeiten: „Haben Sie noch mehr Speck?“ Das mag für die ersten paar Wochen ganz lecker sein, aber langfristig könnte der Mangel an Kohlenhydraten auch die Lebensfreude senken – und das ganz ohne Pizza.
Der vegane Lebensstil erfreut sich immer größerer Beliebtheit, und viele Menschen schwören auf die gesundheitlichen Vorteile der pflanzlichen Ernährung. Vegan zu essen bedeutet, auf alle tierischen Produkte zu verzichten und sich ausschließlich pflanzlich zu ernähren.
Die Wissenschaft: Eine gut geplante vegane Ernährung kann durchaus gesundheitliche Vorteile bieten, darunter ein geringeres Risiko für Herzkrankheiten, Bluthochdruck und bestimmte Krebsarten. Es ist jedoch wichtig, auf eine ausreichende Zufuhr von Vitamin B12, Eisen und Omega-3-Fettsäuren zu achten –hier besteht häufig ein Mangel.
Wie es sich anfühlt: Vegan zu leben kann sich wie ein ständiges „Komm schon, iss das Salatblatt!“ anfühlen, besonders wenn man von Freunden zum Grillen eingeladen wird und nur das Gemüse-Patty übrig bleibt. Doch wer ein gutes Rezept für veganen Schokoladenkuchen hat, wird schnell zum Star der nächsten Party und rettet nebenbei die Welt.
Eine guter Kompromiss ist es, zunächst auf pflanzenbetonte Ernährung umzustellen. Das lässt mehr Freiheiten, sich auszuprobieren.
Intervallfasten:
Nicht essen ist auch eine
Intervallfasten hat sich zu einem der angesagtesten Trends entwickelt. Das Prinzip ist einfach: Man fastet für bestimmte Zeiträume, zum Beispiel etwa 16 Stunden täglich, und hat dann ein Zeitfenster von 8 Stunden, in dem gegessen wird.

Die Wissenschaft: Einige Studien zeigen, dass Intervallfasten zu einer Gewichtsreduktion führen und die Insulinempfindlichkeit verbessern kann. Allerdings gibt es noch keine eindeutigen Langzeitstudien, die die Auswirkungen auf die allgemeine Gesundheit belegen. Für viele könnte das Fasten jedoch auch zu einem gesteigerten Bewusstsein für den eigenen Körper und Essgewohnheiten führen.
Wie es sich anfühlt: Intervallfasten fühlt sich manchmal wie ein Spiel an – „Wie lange kann ich es schaffen, bevor der Bäcker um die Ecke ruft?“ Aber wenn man es richtig macht, fühlt man sich vielleicht sogar wie ein „Essens-Yogi“: Ganz entspannt, nur noch mit einem gesunden Smoothie und einer inneren Ruhe, die einem sagt, dass der Burger doch noch 4 Stunden warten kann. Mit dem Burger ist Abnehmen dann allerdings nicht garantiert.
Die Forschung zur Ernährung ist in den letzten Jahrzehnten explodiert und viele Studien bieten spannende Einblicke in die Auswirkungen verschiedener Ernährungsweisen. Eine bemerkenswerte Studie ist die „PREDIMED“-Studie aus Spanien, die den Zusammenhang zwischen der mediterranen Ernährung und der Prävention von Herz-Kreislauf-Erkrankungen untersuchte. Das Ergebnis: Die mediterrane Diät, die reich an Obst, Gemüse, Nüssen, Fisch und gesunden Fetten ist, senkt das Risiko für Herzkrankheiten erheblich.
Eine andere bemerkenswerte Forschung kommt von der Harvard T.H. Chan School of Public Health, die in einer Meta-Analyse von 2015 zeigte, dass eine pflanzenreiche Ernährung das Risiko für chronische Krankheiten wie Diabetes, Bluthochdruck und bestimmte Krebsarten verringern kann.
Besonders wichtig ist es, bei der Auswahl der Ernährungsempfehlungen auf Langzeitstudien zu achten. Kurzfristige Studien können zwar faszinierende Ergebnisse liefern, doch die wahren Auswirkungen einer Ernährungsform auf die allgemeine Gesundheit zeigen sich erst über Jahre oder Jahrzehnten. Die größte Herausforderung der Ernährungsforschung bleibt es, die langfristigen Folgen einer Diät zu erfassen und herauszufinden, welche diätetischen Muster den größten Einfluss auf die Lebenserwartung und Lebensqualität haben.
In diesem Zusammenhang sind interdisziplinäre Studien besonders wertvoll, die nicht nur die Auswirkungen der Ernährung auf das Gewicht, sondern auch auf chronische Krankheiten, das Mikrobiom und die psychische Gesundheit untersuchen. Das Bild wird immer komplexer, aber es zeigt auch, wie individuell die ideale Ernährung für jeden Einzelnen aussehen muss.
Ein paar Grundlagen sind immerhin unumstritten: Eine gesunde Ernährung besteht aus einer ausgewogenen Mischung aus Nährstoffen, die der Körper benötigt, um optimal zu funktionieren. Es geht nicht nur darum, Kalorien zu zählen (obwohl das auch wichtig ist), sondern vielmehr darum, eine ausgewogene Aufnahme von Makro- und Mikronährstoffen zu gewährleisten.
n Makronährstoffe: Kohlenhydrate, Proteine und Fette sind die großen Drei. In den letzten Jahren gab es viel Diskussion darüber, wie viel von jedem dieser Nährstoffe konsumiert werden sollte. Die Wahrheit ist: Es kommt darauf an! Eine Ernährung mit einem hohen Anteil an komplexen Kohlenhydraten (z B. Vollkornprodukte) und hochwertigen Fetten (wie Olivenöl oder Nüssen) sowie ausreichend Proteinen (vor allem pflanzliche Quellen wie Hülsenfrüchte und Tofu) ist nachweislich vorteilhaft für die Gesundheit.
n Mikronährstoffe: Vitamine und Mineralstoffe sind die kleinen Helden im Hintergrund, die in der Ernährung oft unterschätzt werden. Aber ohne sie läuft nichts rund – von der Immunabwehr bis hin zu einem gesunden Stoffwechsel. Eine bunte Mischung aus Gemüse, Obst und Vollkornprodukten sorgt hier für eine reiche Versorgung.
n Ballaststoffe: Ein oft unterschätzter Faktor in der Diskussion über gesunde Ernährung sind Ballaststoffe. Diese komplexen Kohlenhydrate, die der Körper nicht vollständig verdauen kann, sind für die Gesundheit unerlässlich. Sie tragen nicht nur zur Verdauung bei, sondern wirken auch präventiv gegen zahlreiche Erkrankungen wie Herzkrankheiten und Diabetes. Studien haben immer wieder gezeigt, dass Menschen mit einer ballaststoffreichen Ernährung ein geringeres Risiko für chronische Krankheiten haben. Empfohlen werden etwa 25– 30 Gramm Ballaststoffe pro Tag. Wer viel Obst, Gemüse, Vollkornprodukte und Hülsenfrüchte isst, wird sich in der Regel schnell an diese Menge herantasten – und das ohne das Gefühl, sich zum Essen zu zwingen.


















Ihre Gesundheit ist unbezahlbar. Sie privat abzusichern nicht.
Landesdirektion
Landesdirektion


Die optimale Ernährung für die Gesundheit ist eine, die keine extremen Einschnitte oder Dogmen erfordert, sondern vielmehr eine flexible, ausgewogene Herangehensweise. Die Wahrheit ist, dass es nicht nur „die eine“ richtige Diät gibt. Der Schlüssel liegt in der Balance: eine Mischung aus guten Kohlenhydraten, Proteinen, gesunden Fetten und ausreichend Mikronährstoffen. Dazu eine Prise Genuss und das gelegentliche Stück Kuchen, ohne schlechtes Gewissen.
Es gibt keinen „One-Size-Fits-All“-Ansatz, wenn es um Ernährung geht. Der Körper jedes Menschen reagiert anders auf bestimmte Nahrungsmittel und Ernährungsweisen. Während eine Person mit einer Low-Carb-Diät Erfolg hat, kann eine andere mit einer vollwertigen, pflanzlichen Ernährung die besten Resultate erzielen. Der wahre Schlüssel liegt darin, auf die Signale des eigenen Körpers zu hören und die Ernährung an die individuellen Bedürfnisse und Ziele anzupassen.
Es kommt auf den Mix an!

Milchbackenzahnung, Ernährungsberatung
21. – 24. Monat n Kinderheilkunde u U7 aus dem Baby ist ein Kleinkind geworden
24. Monat n Akademische u Früherkennung und Beratung von Risikokindern („Late-talker“) Sprachtherapie n HNO-heilkunde n Augenheilkunde u Ausschluss frühkindliches Schielen





Versicherungsdienst GmbH


Die Welt der Ernährung ist so facettenreich wie unsere individuellen Vorlieben und Bedürfnisse. Die neueste Diät ist nicht immer die beste Wahl für jeden – und oft liegt der wahre Schlüssel in einer ausgewogenen und abwechslungsreichen Ernährung. Wenn wir die Ernährungstrends mit einer gewissen Portion Entspannung und gesundem Menschenverstand betrachten, können wir die besten Teile davon in unseren Alltag integrieren. n
30. – 72. Monat n Zahnmedizin u 3 x FU: Einschätzung Kariesrisiko, Ernährungsberatung, Mundhygieneberatung, Fluoridmittelempfehlung
34. – 36. Monat n Kindheilkunde u U7a Kleinkind wird Kindergartenkind
3. – 4. Lebensjahr n Akademische u Beratung und Frühförderung zu Prophylaxe von Stimm-, Sprach-, Sprech- und Sprachtherapie Schluckstörungen; Elternberatung und -anleitung bei kindlichen Stimm-, Sprach-, n HNO-heilkunde Sprech- und Schluckstörungen sowie bei Stottern; Beratung fremdsprachiger Eltern bei Verdacht auf Sprach- oder Sprechstörung bei Mehrsprachigkeit
4. Lebensjahr n Augenheilkunde u Ausschluss Schwachsichtigkeit, Spätschielen, Brille n Kinderheilkunde u U8 auf dem Weg zum Vorschulkind
5. Lebensjahr n Kinderheilkunde u U9 bald ein Schulkind
Großostheim

Geschäftstelle
Also, wie so oft gilt:
Geschäftstelle
Geschäftstelle
Alexander Fuchs Jochen Beez
Alexander Fuchs Jochen Beez
Alexander Fuchs Jochen Beez
63785 Obernburg am Main 06026 995866 Tel. 06022 31568
Die Wahrheit liegt in der Mitte –und in einer Mahlzeit, die Spaß macht und dem Körper gut tut.
63762 Großostheim 63785 Obernburg am Main Tel. 06026 995866 Tel. 06022 31568
Großostheim 63785 Obernburg am Main
Geschäftsstelle

6. Lebensjahr n Augenheilkunde u Ausschluss Schwachsichtigkeit, Brille vor Einschulung n HNO-heilkunde u Allergietest n Urologie u Harnsteinfrüherkennung bei familiärer Veranlagung für Nierensteine
ab 6. Lebensj. halbj. n Zahnmedizin u 01, Prophylaxe (IP), Fissurenversiegelung
7. Lebensjahr n Kieferorthopädie u U8/U9 Erkennen von Kieferfehlstellungen
8. Lebensjahr n Akademische u Diagnostik und Therapie von Lese- und Rechtschreibstörungen Sprachtherapie
9. Lebensjahr n Kieferorthopädie u Voruntersuchung Ende der 1. Wechselgebissphase
06026 995866 Tel. 06022 31568
Geschäftsstelle
Geschäftsstelle
Eisert
Willibald Eisert
ab 10. Lebensjahr n HNO-heilkunde u Hörtest, Prüfung des Gleichgewichtes auf Tauch-, Fahr-, Flug- und Bootstauglichkeit, Tauglichkeitsuntersuchung für bestimmte Berufe (Piloten, Berufskraftfahrer, Sprechberufe)

Geschäftsstelle
Willibald Eisert Wolfgang Bätz
63768 Hösbach
Tel. 06021 592700 Alexander Fuchs 63762 Großostheim Tel. 06026 995866 63785 Obernburg a. Main 63920 Großheubach Tel. 09371 6693676 Landesdirektion Versicherungsdienst GmbH
Hösbach
06021 592700
Geschäftsstelle
Willibald Eisert Wolfgang Bätz
63768 Hösbach
Geschäftsstelle
Hösbach 63920 Großheubach 06021 592700 Tel. 09371 6693676 bleibt.
bleibt.

Vertrauen, das bleibt.
Wolfgang Bätz
63920 Großheubach
Tel. 09371 6693676

11. Lebensjahr n Kieferorthopädie u Voruntersuchung Ende der 2. Wechselgebissphase
12. – 18. Lebensj. halbj. n Zahnmedizin u 01, Prophylaxe (IP), Versiegelung, KFO-Ber., OPG für Check Weisheitszähne, Bissflügelaufnahmen
bis 13. Lebensjahr n Kieferorthopädie u 9. – 13. Lebensjahr Beseitigung von Zahn- und Kieferfehlstellungen
13. – 14. Lebensjahr n Kieferorthopädie u 9. – 13. Lebensjahr Beseitigung von Zahn- und Kieferfehlstellungen n Kinderheilkunde u J 1 Jugendlichen-Untersuchung
16. – 17. Lebensjahr n Frauenheilkunde u Impfung gegen Gebärmutterhalskrebs, Antikonzeptionberatung n Kinderheilkunde u J 2 Jugendlichen-Untersuchung
63920 Großheubach Tel. 06021 592700 Tel. 09371 6693676
17. Lebensjahr n Kieferorthopädie u Entscheidung ob Behandlung auf Kassenkosten
10. – 18. Lebensjahr n Orthopädie u Rücken-Check-up
1. – 18. Lebensjahr n Dermatologie u Hautvorsorgeuntersuchung bei großen angeborenen Muttermalen oder familiärem Hautkrebs n Urologie u Harnsteinfrüherkennung bei familiärer Veranlagung, Hodenkrebsfrüherkennung bei jungen Männern (15. – 40. Lebensjahr jährlich)

Lebensalter Fachrichtung Art der Untersuchung ab 18. Lebensjahr n Augenheilkunde u Verkehrstauglichkeit/Brille bei Führerschein mit 17 Jahren
n Urologie u Fruchtbarkeitscheck bei (unerfülltem) Kinderwunsch, Harnsteinfrüherkennung bei familiärer Veranlagung, Hodenkrebsfrüherkennung bei jungen Männern (15. – 40. Lebensjahr jährlich)
n Zahnmedizin u regelmäßige ½-Jahres-Kontrollen
20. Lebensjahr n Augenheilkunde u „Fit fürs Fahren“, Autofahrer-Check
n Frauenheilkunde u Krebsvorsorgeuntersuchung
n HNO-heilkunde u Hörtest (Früherkennung von Lärmschäden), bei Rauchern 2 x jährlich Kehlkopfspiegelung zur Früherkennung des Kehlkopfkrebses, Tauchtauglichkeitsuntersuchung zur Verhinderung von Barotraumen des Ohres und der Nasennebenhöhlen
n Innere Medizin u Stoffwechsel-Check, Kontrolle von Impfschutz, Indentifizierung von Risikopatienten (z B. fam. Polyposen)
n Kardiologie u bei Leistungssport: alle 2 Jahre Fitness-Check (EKG, Ergometrie, Ergospirometrie, Lungenfunktion, Echokardiogramm, Laborwerte)
n Kieferorthopädie u Verlaufskontrolle
n Neurologie u Schlafanalyse und -hygiene
n Orthopädie u Rücken-Check-up alle 5 Jahre
n Sportmedizin u bei Leistungssport: alle 2 Jahre Fitness-Check (EKG, Ergometrie, Lungenfunktion, Echokardiogramm, Laborwerte)
n Urologie u Harnsteinfrüherkennung bei familiärer Veranlagung, Hodenkrebsfrüherkennung bei jungen Männern (15. – 40. Lebensjahr jährlich)
n Zahnmedizin u regelmäßige ½-Jahres-Kontrollen 01, PSI-Code (Check PAR), Prophylaxe, Vorsorge Kiefergelenk, Vorsorge Rö-Aufnahmen für Kariesdiagnostik und Ausschluss krankh. Veränderungen

Lebensalter Fachrichtung Art der Untersuchung
n Innere Medizin u erstmalige Krebsvorsorge mit Coloskopie, Oberbauchsonografie und fakultativer Gastroskopie, Labor alle 5 Jahre n Kardiologie u erstmaliger genereller Herz-Kreislauf-Check (EKG, Ergometrie, Ergospirometrie, Lungenfunktion, Echokardiogramm, Laborwerte, Duplexsonographie der hirnversorgenden Arterien, Ultraschall Beinarterien) n Orthopädie u Osteoporosemessung, Rücken-Check alle 5 Jahre n Radiologie u Herz-CT-Koronarangiografie: Ausschluss KHK, Diabetiker, Bypasskontrolle; Herz-CT-Kalzium-Score: familiäres Infarktrisiko, Raucher, Diabetiker, Hypercholesterinämie, Gefäß-Check der hirnversorgenden Gefäße (Arterien); mittels MR-Angiografie: bei Diabetikern, Rauchern, fam. Schlaganfall und Hypercholesterinämie
n Urologie u Männer: Prostata-, Harnblasen-, Nierenkrebs- und Harnsteinfrüherk. (jährl.); Frauen: Harnblasen-, Nierenkrebs- und Harnsteinfrüherk. (jährl.)
n Zahnmedizin u regelmäßige ½-Jahres-Kontrollen 01, PSI-Code (Check PAR), Prophylaxe, Vorsorge Kiefergelenk, Vorsorge Rö-Aufnahmen für Kariesdiagnostik und Ausschluss krankh. Veränderungen
50. Lebensjahr n Augenheilkunde u Verkehrs- Check (LKW alle 5 Jahre), Bildschirmbrille, Glaukomfrüherkennung, Netzhautvorsorge in medikamentöser Mydriasis, „Fit fürs Fahren“, Autofahrer-Check
n Frauenheilkunde u Krebsvorsorge mittels Mammografie, Mammasonografie, Vaginalsonografie und Dünnschichtzytologie
n Gefäßchirurgie u Gefäß-Check bei Rauchern und Hypertonikern
n Innere Medizin u ausführlicher Check-up mit EKG, Ergometrie, Labor, Lungenfunktion, Sonografie von Schilddrüse und Oberbauch – Wiederholung alle 5 Jahre; Krebsvorsorge mit Coloskopie, Oberbauchsonografie und fakultativer Gastroskopie, Labor alle 5 Jahre
n Kardiologie u Herz-Kreislauf-Check (EKG, Ergometrie, Ergospirometrie, Lungenfunktion, Echokardiogramm, Laborwerte, Duplexsonographie der hirnversorgenden Arterien) – Wiederholung alle 5 Jahre; bei Freizeitsport: alle 2 Jahre FitnessCheck (EKG, Ergospirometrie, Lungenfunktion, Echokardiogramm, Laborwerte)
n Kieferorthopädie u Verlaufskontrolle
n Neurologie u Früherkennung dementieller Störungen, Neuropsychol. Untersuchungen n Radiologie u Darmkrebsvorsorge (virtuelle CT-Darmspiegelung)
n Sportmedizin u alle 2 Jahre sportmed. Untersuchungen
n Urologie u Männer: Prostata-, Harnblasen-, Nierenkrebs- und Harnsteinfrüherk. (jährl.); Frauen: Harnblasen-, Nierenkrebs- und Harnsteinfrüherk. (jährl.)
30. Lebensjahr
n Augenheilkunde u „Fit fürs Fahren“, Autofahrer-Check
n Frauenheilkunde u Krebsvorsorgeuntersuchung, Mammasonografie, Dünnschichtzytologie
n Innere Medizin u komplette Krebsvorsorge alle 5 Jahre, Komplett-Check alle 2 Jahre
n Kieferorthopädie u Verlaufskontrolle n Radiologie u Brustkrebsvorsorge Mammasonografie (30., 40. Lebensjahr); bei familiärem Risiko: Mamma-MRT n Urologie u Harnsteinfrüherkennung bei familiärer Veranlagung, Hodenkrebsfrüherkennung bei jungen Männern (15. – 40. Lebensjahr jährlich)
n Zahnmedizin u regelmäßige ½-Jahres-Kontrollen 01, PSI-Code (Check PAR), Prophylaxe, Vorsorge Kiefergelenk, Vorsorge Rö-Aufnahmen für Kariesdiagnostik und Ausschluss krankh. Veränderungen 40. Lebensjahr n Augenheilkunde u Glaukomfrüherkennung, Netzhautvorsorge in medikamentöser Mydriasis, „Fit fürs Fahren“, Autofahrer-Check
n Frauenheilkunde u Krebsvorsorgeuntersuchung mittels Mammografie, Mammasonografie, Vaginalsonografie und Dünnschichtzytologie
n Innere Medizin u ausführlicher Check-up mit EKG, Ergometrie, Labor, Lungenfunktion, Sonografie von Schilddrüse und Oberbauch – Wiederholung alle 5 Jahre
n Innere Medizin/ u bei Freizeitsport: alle 5 Jahre Check (EKG, Ergometrie, Lungenfunktion, Sportmedizin Echokardiogramm, Laborwerte)
n Kardiologie u bei Freizeitsport: alle 2 Jahre Fitness-Check (EKG, Ergospirometrie, Lungenfunktion, Echokardiogramm, Laborwerte); bei Risiko-Patienten (Herzinfarkt in der Familie, Bluthochdruck, Zuckerkrankheit, Blutfetterhöhung, Rauchen): EKG, Ergometrie, Ergospirometrie, Lungenfunktion, Echokardiogramm, Duplexsonographie der hirnversorgenden Arterien, Ultraschall Beinarterien, Laborwerte
n Kieferorthopädie u Verlaufskontrolle
n Neurologie u Schlaganfallprävention (Stroke risk analyser)
n Radiologie u Lungenkrebsvorsorge (Lungen-CT), Mammasonografie
n Sportmedizin u alle 5 Jahre sportmed. Untersuchungen
n Urologie u Männer: Prostata-, Harnblasen-, Nierenkrebs- und Harnsteinfrüherk. (jährl.); Frauen: Harnblasen-, Nierenkrebs- und Harnsteinfrüherkennung (jährl.)
n Zahnmedizin u regelmäßige ½-Jahres-Kontrollen 01, PSI-Code (Check PAR), Prophylaxe, Vorsorge Kiefergelenk, Vorsorge Rö-Aufnahmen für Kariesdiagnostik und Ausschluss krankh. Veränderungen
45. Lebensjahr n Augenheilkunde u Glaukomfrüherkennung, Netzhautvorsorge in medikamentöser Mydriasis, „Fit fürs Fahren“, Autofahrer-Check, Bildschirmbrille
n Frauenheilkunde u Knochendichte, Krebsvorsorge mittels Mammografie, Mammasonografie, Vaginalsonografie und Dünnschichtzytologie
n Zahnmedizin u regelmäßige ½-Jahres-Kontrollen 01, PSI-Code (Check PAR), Prophylaxe, Vorsorge Kiefergelenk, Vorsorge Rö-Aufnahmen für Kariesdiagnostik und Ausschluss krankh. Veränderungen
60. Lebensjahr n Akademische u Beratung u. Diagnostik von dementiellen Erkrankungen z B. CERAD Sprachtherapie
n Augenheilkunde u Verkehrs- Check (LKW alle 5 Jahre), Bildschirmbrille, Glaukomfrüherkennung, Netzhautvorsorge in medikamentöser Mydriasis, „Fit fürs Fahren“, Autofahrer-Check
n Frauenheilkunde u Krebsvorsorge mittels Mammografie, Mammasonografie, Vaginalsonografie und Dünnschichtzytologie
n HNO-heilkunde u Hörtest
n Innere Medizin u ausführl. Check-up mit EKG, Ergometrie, Labor, Lungenfunktion, Sonografie von Schilddrüse u. Oberbauch – Wiederholung alle 2 Jahre
n Kardiologie u Herz-Kreislauf-Check (EKG, Ergometrie, Ergospirometrie, Lungenfunktion, Echokardiogramm, Laborwerte, Duplexsonographie der hirnversorgenden Arterien, Ultraschall Beinarterien) – Wiederholung alle 5 Jahre; bei Freizeitsport: alle 2 Jahre Fitness-Check (EKG, Ergospirometrie, Lungenfunktion, Echokardiogramm, Laborwerte)
n Kieferorthopädie u Verlaufskontrolle
n Sportmedizin u bei Freizeitsport: alle 2 Jahre Check (EKG, Ergometrie, Lungenfunktion, Echokardiogramm, Laborwerte)
n Urologie u Männer: Prostata-, Harnblasen-, Nierenkrebs- und Harnsteinfrüherk. (jährl.); Frauen: Harnblasen-, Nierenkrebs- und Harnsteinfrüherk. (jährl.)
n Zahnmedizin u regelmäßige ½-Jahres-Kontrollen 01, PSI-Code (Check PAR), Prophylaxe, Vorsorge Kiefergelenk, Vorsorge Rö-Aufnahmen für Kariesdiagnostik und Ausschluss krankh. Veränderungen
ab 70. Lebensjahr n Augenheilkunde u Bildschirmbrille, Glaukomfrüherkennung, Netzhautvorsorge in medikamentöser Mydriasis, „Fit fürs Fahren“, Autofahrer-Check
n Frauenheilkunde u Krebsvorsorge mittels Mammografie, Mammasonografie, Vaginalsonografie und Dünnschichtzytologie n Orthopädie u Rücken-Check-up alle 5 Jahre n Urologie u Männer: Prostata-, Harnblasen-, Nierenkrebs- und Harnsteinfrüherk. (jährl.); Frauen: Harnblasen-, Nierenkrebs- und Harnsteinfrüherk. (jährl.) n Zahnmedizin u regelmäßige ½-Jahres-Kontrollen 01, PSI-Code (Check PAR), Prophylaxe, Vorsorge Kiefergelenk, Vorsorge Rö-Aufnahmen für Kariesdiagnostik und Ausschluss krankh. Veränderungen
Alle Altersklassen n Dermatologie u Hautvorsorgeuntersuchung 1 x jährlich; insbesondere bei mehr als 50 Muttermalen, häufigen Sonnenbränden, Hellhäutigen und Rothaarigen sowie bei familiärem Hautkrebs

Risikogruppe Fachrichtung Art der Untersuchung
Berufsgruppen
– Berufskraftfahrer n Augenheilkunde u ab 50. Lebensjahr 5-jährlich
n HNO-heilkunde u ab 50. Lebensjahr 5-jährlich n Urologie u Harnblasenkrebsfrüherkennung
– Piloten n Augenheilkunde u gemäß Bestimmung 2-jährlich n HNO-heilkunde u gemäß Bestimmung n Kardiologie/Innere Med. u gemäß Bestimmung jährlich
– Bildschirmarbeitsplatz n Augenheilkunde u ab 45. Lebensjahr 2-jährlich n Orthopädie u 5-jährlich Rücken-Check-up
– Bei Feuchtarbeiten, irritativen und n Dermatologie u gemäß berufsgenossenschaftlichen Bestimmungen sensibilisierenden Arbeitsstoffen
– Leder-, Gummi-, Textilindustrie, n Urologie u Harnblasenkrebsfrüherkennung Kaminkehrer, Bauindustrie, Friseure, Exposition gegenüber Lacken, Farben, Lösungsmitteln, Haarfärbemitteln
Diabetiker n Augenheilkunde u jährliche Netzhautuntersuchungen n Diabetologie u 3-monatliche Untersuchungen
n Dermatologie u individuell, Haut-Check
n Kardiologie u ab 45. Lebensjahr alle 5 Jahre n Radiologie u ab 45. Lebensjahr jährlich n Zahnmedizin u regelmäßige Parodontitisvorsorge/Kontrolle
Fam. Herzinfarkt/Schlaganfall-Belast. n Kardiologie u ab 45. Lebensjahr alle 5 Jahre
Herzkranke n Kardiologie/Innere Med. u alle 6 – 12 Monate, je nach Schwere der Erkrankung n Zahnmedizin u regelmäßige Parodontitisvorsorge/Kontrolle
Hypertoniker n Augenheilkunde u jährliche Netzhaut- und Augendruckuntersuchungen
n Gefäßchirurgie u Gefäß-Check
n Innere Medizin u 6-monatliche Untersuchungen
n Kardiologie u je nach Alter, ab 45. Lebensjahr alle 5 Jahre
Immunschwäche n Dermatologie u Hautvorsorgeuntersuchung individuell bei Krebserkrankungen, Lymphomen, Leukämie, organtransplantierten Patienten, HIV Infektion, sowie Einnahme immununterdrückender Medikamente (z B. Cortison, Imurek u.a.) n Zahnmedizin u Überwachung von Infektionen in der Mundhöhle
Kurzsichtige n Augenheilkunde u ab -3,0 dpt jährlich Netzhaut-Check
Medikamentendauereinnahme
– Antikozeptiva/Hormonersatztherapie n Frauenheilkunde u 6-monatlich
– Biologicals n Dermatologie u individuell, Haut-Check
– Bisphosphonate n Zahnmedizin u Zahnsanierung vor Therapiebeginn und regelmäßige Überwachung
– Cortison n Augenheilkunde u 6-monatlich
n Dermatologie u individuell, Haut-Check
n Innere Medizin u 3-monatlich n Orthopädie u Messung von Osteoporose und Muskelmasse
– Chemotherapeutika (MTX, etc.) n Augenheilkunde u jährlich Gaucom-, Hornhaut-, Netzhaut-Check n Dermatologie u individuell, Haut-Check n Onkologie u Nachsorge 3-monatlich (individuell) n Urologie u Harnblasenkrebsfrüherkennung n Zahnmedizin u vor Chemotherapie Vorstellung, ggf. Zahnsanierung und regelmäßige Kontrolle
Risikogruppe Fachrichtung Art der Untersuchung
– ß-Blocker n Kardiologie/Innere Med. u jährlich
– Cordarex n Augenheilkunde u jährlich Hornhaut-, Netzhaut-Check n Kardiologie/Innere Med. u jährlich
– Antirheumatika n Augenheilkunde u jährlich Hornhaut-, Netzhaut-Check (Gold, Resochin, MTX) n Dermatologie u individuell, Haut-Check n Innere Medizin u 3-monatlich
– Lichtsensibilisierende Pharmaka n Dermatologie u individuell, Haut-Check (z B. Tetracycline)
– Bestrahlung n Zahnmedizin u vor Therapiebeginn Vorstellung, ggf. Zahnsanierung und regelmäßige Kontrolle
Osteoporose n Orthopädie u ab 45. Lebensjahr: 1 x jährlich Osteoporosemessung
Raucher n Augenheilkunde u jährliche Netzhautuntersuchung und Glaukomvorsorge n Gefäßchirurgie u Gefäß-Check n HNO-heilkunde u 2 x jährliche Kehlkopfspiegelung
n Innere Medizin u jährlich
n Kardiologie u ab 45. Lebensjahr alle 5 Jahre
n Radiologie u Gefäß-Check 40., 45. Lebensjahr n Urologie u Harnblasenkrebsfrüherkennung
n Zahnmedizin u regelmäßige Parodontitisvorsorge/Kontrolle, Überwachung der Mundschleimhaut
Rheumatiker

Schwangere
n Augenheilkunde u jährlich
n Dermatologie u individuell, Haut-Check
n Innere Medizin u 3-monatlich
n Zahnmedizin u bei Kiefergelenkbeschwerden: regelmäßige Kontrolle
n Frauenheilkunde u Schwangerschaftsvorsorge
n Innere Medizin u Schwangerschaftsdiabetes
n Zahnmedizin u Schwangerschaftsgingivitis/Parodontitis
Sportler n Zahnmedizin u Sportschutzschienen
BERATUNG MIT WEITBLICK, EXPERTISE MIT PRÄZISION.
Wir sind Ihr zuverlässiger Druckpartner im Rhein-MainGebiet mit über fünf Jahrzehnten Erfahrung. Unsere erfahrenen Berater und unser kompetentes ServiceTeam setzen alles daran, Ihre Wünsche zu realisieren. Mit modernster Technik und höchster Präzision meistern wir die anspruchsvollsten Herausforderungen –termingerecht und in bester Qualität.

Ein patentiertes System
kann am Unfallort Leben retten.
GLEIS EINS sprach mit dem Entwickler Kurt Koch.
Damit Personen nach einem Auto-Unfall aus Ihrem Fahrzeug befreit werden können, müssen Rettungskräfte in vielen Situationen die Karosserie zerlegen. Durch moderne Technik sind Fahrzeuge sicherer geworden: Aber wo können die Feuerwehrleute ihre Werkzeuge einsetzen, ohne die Situation zu verschärfen? An welchen Stellen könnten Airbags ausgelöst werden und wo sind Stromschläge zu erwarten? In vielen Unfallsituationen müssen medizinische Fachkräfte schnell auf Informationen zugreifen können, um die richtigen Maßnahmen zu ergreifen, bevor es zu spät ist. Leider ist es nicht immer möglich, diese Informationen in hektischen Situationen schnell zu bekommen. Der schnelle Überblick kann aber am Unfallort lebenswichtig sein.
Der Mainhausener Unternehmer Kurt Koch hat mit SafetyBag ein bestechend einfaches System patentiert, das in jedem Fall verfügbar ist – auch in Regionen, in denen es keinen Handyempfang gibt.
Herr Koch: Was versteht man unter einer SafetyBag?
Um die Bergungszeit nach einem Unfall zu verkürzen, entwickelten die Verbände der Automobilindustrie (VDA und VDIA) im Jahr 2009 gemeinsam mit der Vereinigung zur Förderung des Deutschen Brandschutzes e.V. (vfdb) sogenannte Rettungskarten. Sie zeigen, wo Rettungs-Werkzeug eingesetzt werden kann. Eine SafetyBag ist ein speziell entwickeltes, sicheres Transportmittel für die Rettungskarte und wichtige medizinische oder sicherheitsrelevante Informationen. Im Allgemeinen wird es in PKW, Transporter oder Reisemobil aufbewahrt und enthält alles, was im Notfall von Rettungskräften oder auch von Ersthelfern sofort eingesehen werden muss. Die SafetyBag kann neben den Fahrzeugplänen unter anderem Notfalldaten wie Allergien, chronische Erkrankungen oder Medikamente enthalten. Im Falle eines Unfalls oder einer medizinischen Notlage spart es wertvolle Zeit und kann Leben retten.

Sie halten das Deutschland und EU Patent der SafetyBag –wie kam es zu dieser Idee?
Die Idee, eine spezielle Tasche zu entwickeln, die wichtige Informationen zum Fahrzeug für Feuerwehren, THW und für Notärzte enthält, kam mir aufgrund eigener Erfahrungen und der Erkenntnis, dass im Falle eines Unfalls schnell auf lebensrettende Informationen zugegriffen werden muss. Ich wollte eine Lösung schaffen, die einfach und dennoch effektiv ist.
Was unterscheidet Ihr Konzept von anderen?
Die SafetyBag bietet Fahrzeugbesitzern eine einfache Lösung, um die Rettungskarte immer griffbereit mitzuführen – es wird an der Windschutzscheibe befestigt und enthält gut sichtbar alle wichtigen Informationen. So sehen die Rettungskräfte, dass es eine Rettungskarte gibt. Verborgene und schlecht zugängliche Plätze wie Sonnenblende oder Handschuhfach sind ungeeignet und können wertvolle Zeit bei der Rettung kosten. Die SafetyBag ist sofort zu erkennen. Sie haftet von innen an der Scheibe und reflektiert Licht bei Dunkelheit. Die Feuerwehr kennt dieses System und kommt auch durch das Glas der Seitenscheibe schnell an die notwendigen Informationen heran. Statt durchschnittlich 50 Minuten dauert die Bergung mit Rettungskarte nur durchschnittlich 17 Minuten – das ist wertvolle Zeit! Unsere SafetyBag enthält zusätzlich zur Rettungskarte einen Unfallhilfe-Ratgeber mit Erste-Hilfe-Maßnahmen, Notrufnummern und Sicherheitsregeln, einen Organspende-Ausweis inkl. Notfallkarte und eine Medicard – Information für Notärzte.
Gibt es auch eine digitale Variante, oder ist das alles ausschließlich in Papierform?
Tatsächlich gibt es mittlerweile auch digitale Lösungen. Diese erfordern jedoch eine gute Netzabdeckung. Aber die Papierform hat große Vorteile, weil sie in jeder Situation sofort verfügbar und für jeden zugänglich ist, in nur einer Minute.
Was gibt es noch zu beachten?
Es ist wichtig, den Inhalt der SafetyBag zu überprüfen und zu aktualisieren. Dinge wie Medikamentenlisten, Allergien oder persönliche Notfallkontakte können sich über die Zeit ändern. Eine regelmäßige Kontrolle sorgt dafür, dass im Fall der Fälle wirklich die richtigen Informationen zur Verfügung stehen. Und bei der Rettungskarte sollte man sicherstellen, dass sie für jedes Fahrzeugmodell korrekt und aktuell ist.









Wo bekommt man Ihr e SafetyBag?
Die SafetyBag kann ganz einfach auf der Online-Plattform www.rettungskarten.eu bestellt werden. Hier erhält der Nutzer auch direkt die individuelle Rettungskarte kostenfrei für sein Fahrzeugmodell im Download bei uns. Denn für jedes Fahrzeugmodell gibt es 1 – 7 A4-Seiten umfassende Rettungskarten oder auch Rettungsdatenblätter. Wir haben das ganz einfach gebündelt verfügbar gemacht.




Kurt Koch: Vision und Engagement
Der Unternehmer Kurt Koch ist der Erfinder der „SafetyBag“, einer Innovation im Bereich der Fahrzeug- und Notfallsicherheit. Seine Idee, eine spezielle Tasche zu entwickeln, die wichtige medizinische und persönliche Notfalldaten enthält, kam ihm aufgrund seiner eigenen Erfahrungen und der Erkenntnis, dass im Falle eines Unfalls schnell auf lebenswichtige Informationen zugegriffen werden muss. Kurt Koch wollte eine Lösung schaffen, die einfach und dennoch effektiv ist. Daher ist die SafetyBag so gestaltet, dass es von den Rettungskräften und auch von Laien leicht gefunden und genutzt werden kann. Dank seiner Vision und seines Engagements für die Sicherheit kann die SafetyBag einen wichtigen Beitrag zur Sicherheit im Straßenverkehr leisten und im Extremfall Leben retten.










Wenn Eltern mit ihren Kindern, die eine Sprachentwicklungsstörung haben, eine logopädische oder sprachtherapeutische Praxis aufsuchen, haben sie oft schon einen langen Leidensweg hinter sich. Therapeu-
tenplätze sind knapp und Fachinformationen im Internet sind oft veraltet oder unvollständig. Der neue Ratgeber „Sprachentwicklungsstörung“ bietet nun eine zuverlässige Quelle, die Eltern, Angehörigen und Fachkräften in Kitas empfohlen werden kann. Die Broschüre erklärt den Verlauf der Sprachentwicklung, beleuchtet Ursachen und Häufigkeit von Sprachentwicklungsstörungen und hilft bei der Suche nach geeigneter Sprachtherapie. Sie ist auch für mehrsprachige Kinder gut geeignet.
(Sprachentwicklungsstörung. Ein Ratgeber für Eltern und pädagogische Fachkräfte in Kita und Schule, C. Lüke, A. Starke, St. Sallat, K. Albrecht; 76 S. 14,50, Schulz-Kirchner-Verlag, 2024)

Kleine Kinder wollen vor allem ihre Umgebung erkunden und sich viel bewegen. Wenn sie auf Bildschirme schauen, kann das Gehirn eines Babys die Bilder und Zusammenhänge noch nicht verstehen, was Stress und Unruhe auslösen kann.
Babys und Kinder bis zu 3 Jahren brauchen keine digitalen Medien für ihre Entwicklung – sie sind sogar schädlich. Aktuelle Studien zeigen, dass Kinder mit hohem Medienkonsum in körperlichen, kognitiven und sprachlichen Tests schlechter abschneiden und auch später in der Schule deutlich schlechtere Noten haben als Klein-

oder gar nicht zu verstehen
Eine Verbale Entwicklungsdyspraxie (VED) ist eine Störung, die die Fähigkeit eines Kindes beeinträchtigt, Sprachlaute richtig zu planen und auszuführen. Kinder mit VED wissen, welches Wort sie sprechen wollen, haben jedoch Probleme, die Wörter herauszubringen. Dies liegt daran, dass das Gehirn nicht in der Lage ist, die einzelnen Muskelbewegungen zur Lautbildung zu koordinieren. Sie haben deshalb große Probleme Laute, Silben und Wörter zu sprechen. Obwohl sie Sprache verstehen, sind durch die Störung der Sprechbewegungen, auch der Aufbau der Sprachlaute, der Wortschatz und der Grammatikerwerb gestört.
kinder ohne Medienkonsum – zusätzlich essen sie mehr Süßes.
Die gesamte Sprachentwicklung bei Kindern geschieht über den Dialog, über Kommunikation und Interaktion. Deshalb ist es wichtig, dass man Kindern etwas vorliest, gemeinsam Bilderbücher anschaut und gemeinsam die Außenwelt erkundet.
Wissenschaftler raten, bei Kleinkindern keinerlei Medienkonsum zuzulassen
Ab 3 bis 4 Jahren sollten Kinder höchstens 20 Minuten täglich, am besten mit einem Elternteil, Medien konsumieren.
Für 4- bis 6-Jährige sind maximal 30 Minuten, für 7- bis 10 -Jährige 45 Minuten und für 11- bis 13 -Jährige maximal eine Stunde täglich empfohlen.
Eltern sollten selbst ein gutes Vorbild in puncto Medienzeit sein und digitale Medien nur bewusst und in bestimmten Zeiten konsumieren. Es ist wichtig, regelmäßig medienfreie Zeiten einzuplanen, in denen sie gemeinsam mit ihren Kindern etwas unternehmen und sie spielerisch fördern.




Sorgenfrei zum Hörgenuss: 6 Jahre
All-in-one!




Etwa 5 –7 % der Kinder sind betroffen, Jungen häufiger als Mädchen. Oft zeigen sich auch Saug-, Schluck- und Kauschwierigkeiten und der Sprechbeginn ist verspätet. Eine frühzeitige, spezielle Sprachtherapie ist wichtig, um die Verständlichkeit der Kinder zu verbessern. Die Therapie sollte intensiv und über einen längeren Zeitraum erfolgen.


HIER FINDEN SIE UNS:
Akademische Praxis für Sprachtherapie
Dr. phil. Ingeborg Maser
Neurolinguistin/Klinische Linguistin dbs/dbl
Frohsinnstraße 28
63739 ASCHAFFENBURG
Telefon 0 60 21/45 27 27
Telefax 0 60 21/45 27 28
www.sprachtherapie-maser.de




So klingt Hörvergnügen inklusive.






Prime Hearing, das ist das glasklare Bekenntnis der Schwind Hörakustik-Spezialisten zu exzellenter Beratung, umfassender persönlicher Hilfestellung und Produktsicherheit nach Maß.
HÖRSYSTEMETAUSCH

Heute an morgen denken, ganz einfach: Tauschen Sie nach 3 Jahren Ihre Hörsysteme gegen das aktuelle Folgemodell. Kostenlos natürlich!
SERVICELEISTUNGEN


Energieversorgung und Wartung sowie Tausch von Verschleißteilen Ihrer Hörsysteme sind während der Laufzeit gratis. Mit 6 Jahren Garantie auf Ihre Hörsysteme sorgt Prime Hearing für langfristige Sicherheit.





Die Urinanalyse ist ein grundlegendes Verfahren in der medizinischen Diagnostik. Sie liefert wichtige Hinweise auf den Gesundheitszustand und hilft dabei, eine Vielzahl von Erkrankungen zu erkennen.
Flüssigkeit, die wir zu uns nehmen, scheiden wir zu einem großen Teil wieder aus – unter anderem in Form von Urin. Als Ausscheidungsprodukt des Körpers, das über die Nieren gebildet wird, dient er zur Regelung des Flüssigkeitshaushalts, Aufrechterhaltung des SäureBasen-Gleichgewichts, Regulation von Elektrolyten sowie zur Entsorgung von Harnstoff, Harnsäure und anderen Stoffwechsel-Endprodukten. So werden mit dem Urin Elemente ausgeschieden, die beim Stoffwechsel anfallen und nicht mehr benötigt werden. Ebenso werden Abfallstoffe wie schädliche Substanzen, die über die Nahrung aufgenommen wurden, oder Medikamente auf diesem Weg eliminiert.
Schon Farbe, Geruch und die Menge des ausgeschiedenen Urins können Hinweise auf Krankheiten, Ernährungsgewohnheiten oder den Flüssigkeitshaushalt geben. So zeigt zum Beispiel wenig und sehr dunkler Urin, dass man zu wenig Flüssigkeit zu sich genommen hat oder etwa die Nierenfunktion beeinträchtigt ist. Trüber und evtl. übelriechender Urin deutet oft auf einen Harnwegsinfekt hin. Eine rötliche Verfärbung des Urins lässt eine Blutbeimengung vermuten.
Die Gewinnung erfolgt durch Auffangen einer Urinprobe in einem Behälter als sogenannter Mittelstrahlurin. Hierbei kommt es beim Mann darauf an, die Vorhaut zurückzuziehen, die zunächst austretende Erstportion zu verwerfen und die darauffolgende Zweitportion aufzufangen, um eine Kontamination vom äußeren Genitalbereich zu vermeiden. Bei der Frau erfolgt dies in gleicher Art und Weise unter Spreizung der äußeren und inneren Schamlippen; alternativ kann hier auch eine Urinent-

Das Urinsediment
Als zweiter Schritt der Urinuntersuchung folgt die mikroskopische Untersuchung. Hierfür muß zunächst ein Urinsediment nach standardisierten Methoden erzeugt werden: 10 ml frischer Urin werden für 5– 8 Minuten bei 1.500- 2.000 U/min. zentrifugiert. Danach wird der Überstand von 9,5 ml verworfen und der Bodensatz in den verbliebenen 0,5 ml mit einer Pipette aufgenommen. Hiervon wird ein Tropfen auf einen Objektträger aufgebracht und abgedeckt.
infektionen, Harnsteinerkrankungen oder Tumorerkrankungen der ableitenden Harnwege hindeuten. Ebenso sind Kristallnachweise für die Harnsteindiagnostik und -therapie sowie Ernährungsberatung zur Steinvorbeugung (Metaphylaxe) wertvoll.
Über die Urinuntersuchung mit Teststreifen in Kombination mit dem Urinsediment gewinnt man somit ein sehr großes Spektrum von Parametern über den Gesundheitszustand des untersuchten Individuums.
In unserer Urologischen Praxis erfolgt der gesamte Urinanalyseprozess vollständig digital und automatisiert mittels Teststreifenleser und digitalem Mikroskop mit Bildanalysesoftware innerhalb von nur 1 Minute mit einer hochgenauen, dem menschlichen Auge überlegenen Urindiagnostikqualität.

Dr. med. Patrick Sawaya
nahme durch Einmalkatheterisierung durchgeführt werden. Nach der Gewinnung wird die Probe zeitnah analysiert, da längere Standzeiten die Ergebnisse ebenso verfälschen.
Die Urinprüfung mittels Urinteststreifen
Als erster Schritt der Urinuntersuchung erfolgt die Prüfung mit einem Teststreifen, der mit verschiedenen reaktiven Feldern beschichtet ist und für wenige Sekunden eingetaucht wird. Gibt es nach einer Interaktionszeit von ca. 1 Minute eine Reaktion mit dem jeweiligen Testfeld, ändert dieses seine Farbe. Die Bestimmung der Farbänderung erfolgt entweder mit dem Auge durch Vergleich mit Farbskalen oder automatisiert mittels eines Teststreifenlesers.
Typische Testparameter sind:
• Leukozyten: Hinweis auf Infektionen
• Nitrit: Hinweis auf Harnwegsinfekte
• Eiweiss (Protein): Hinweis auf Nierenerkrankungen
• Glukose: Hinweis auf Diabetes
• Ketone: Hinweis auf Fettstoffwechselstörungen
• pH-Wert: Säure-Basen-Gleichgewicht
• Blut (Hämoglobin/Erythrozyten): Hinweis auf Verletzungen, Infektionen, Harnsteine, Nierenerkrankungen oder Tumore
• Urobilinogen und Bilirubin: Hinweis auf Leber- oder Gallenblasenerkrankungen
• Spezifisches Gewicht / Dichte des Urins: Hinweis auf Flüssigkeitsmangel, Elektrolytstörungen oder Nierenerkankungen
Unter dem Phasenkontrastmikroskop werden nun bei 400-facher Vergrößerung die festen ungelösten Bestandteile des Urins wie Zellen, Kristalle, Bakterien oder Zylinder durch Betrachten von 15 verschiedenen Ausschnitten der Urinprobe, sogenannten Gesichtsfeldern (GF), analysiert. Die exakte Auszählung von Zellen im Sediment kann zusätzlich mittels einer genormten Zählkammer erfolgen. Die Sedimentgewinnung und -analyse kann heutzutage auch hochpräzise automatisiert erfolgen. Hierfür muss ein spezieller MiniaturUrinbehälter, sogenannte Küvette, mit 165 µl frischem Urin über eine Standardpipette befüllt werden. Nach kurzer Zentrifugation nimmt das Analysesystem selbstständig 15 Bilder mit dem eingebauten digitalen Mikroskop auf und bewertet sie mit Hilfe eines Auto Image Evaluation Moduls (AIEM), einer hochwertigen Bildanalysesoftware. Auf diese Weise kann ein Urinsediment mit höchster Präzision innerhalb von weniger als einer Minute erzeugt und detaillierte Informationen über mögliche Erkrankungen gewonnen werden.
Es finden sich folgende physiologische Bestandteile:
• 0– 2 rote Blutkörperchen (Erythrozyten) pro Gesichtsfeld
• 0– 4 weisse Blutkörperchen (Leukozyten) pro Gesichtsfeld
• Vereinzelt abgeschilferte Epithelzellen der Schleimhaut der ableitenden Harnwege von Nierenbecken, Harnleiter, Harnblase und Harnröhre
• Vereinzelt Zylinder (längliche zusammengelagerte zelluläre oder proteinbasierte Strukturen, die in den Nierenkanälchen entstehen und als Abgüsse dieser Tubuli in den Urin gelangen)
• Vereinzelt Kristalle (z B. Kalziumoxalate, Harnsäurekristalle oder Phosphate)
• Vereinzelt Bakterien
Die Beurteilung der Form der roten Blutkörperchen und die Feststellung von Zylinderformationen von Blutzellen oder proteinbasierten Strukturen ermöglicht die Differenzierung zwischen Erkrankungen der Nieren und unteren Harnwege.
Erhöhte Zahlen von Erythrozyten und Leukozyten können auf unterschiedliche Arten von chronischen Nierenerkrankungen, Harnwegs-
Die Urinkultur und Erregeridentifikation
Gibt es im Urinsediment hinreichenden Anhalt für das Vorliegen einer Harnwegsinfektion durch Nachweis erhöhter Zahlen von roten und/oder weissen Blutkörperchen sowie Bakterien, möglicherweise ergänzt durch einen positiven Nitrit-Nachweis im Urinteststreifen (Stoffwechselprodukt bestimmter Bakterien), wird eine Urinkultur angelegt. Hierbei werden einige Milliliter des Urins auf mikrobiologischen Nährböden in Petrischalen ausgestrichen und diese dann für 24 Stunden bei 37 Grad im Brutschrank inkubiert. Dies ermöglicht es den vorhandenen Erregern sich auszubreiten. Auf diese Weise wird die Keimdichte und somit Intensität der Infektion sichtbar.
Im weiteren erfolgt dann mit Hilfe des angezüchteten Keimmaterials eine Erregeridentifizierung durch dessen Enzymaktivitäten, Substratabbau und gewisse bakterielle Fähigkeiten durch Farbumschlag verschiedener mit dem Keim beimpfter reaktiver Nährmedien. Abschließend wird eine Resistenzbestimmung gegenüber den gängigen antibiotischen Substanzen durchgeführt. Bei diesem sogenannten Agardiffusionstest werden Agarplatten mit dem zu testenden Keim beimpft und Antibiotika-Testplättchen auf die Plattenoberfläche gelegt. Während einer 24-stündigen Bebrütungsphase diffundiert die antibiotische Substanz in das Agarmedium und verhindert in der Umgebung je nach Erregerempfindlichkeit in unterschiedlichem Ausmass das Keimwachstum, sodass ein sogenannter Hemmhof mit fehlendem Bakterienwachstum entsteht. Aus der Vermessung des Hemmhofdurchmessers lassen sich Rückschlüsse auf die Empfindlichkeit eines Erregers gegenüber einem antibakteriellen Wirkstoff ziehen und ein Antibiogramm erstellen. Dies ist die Basis zur Auswahl des geeigneten Antibiotikums für die Behandlung des vorliegenden Harnwegsinfekts. Somit kann innerhalb von 48 Stunden eine exakt auf den jeweiligen Keim abgestimmte antibiotische Therapie erfolgen.


Krebsvorsorgeuntersuchungen


Geschlechtserkrankungen





Fruchtbarkeitsuntersuchungen bei unerfülltem Kinderwunsch




Nieren- und Harnleitererkrankungen Kinderurologie Ambulante Prostatakrebstherapie durch SeedImplantation

und Endoskopie

Prostata- und Samenblasenerkrankungen

Wir sind Mitglied im Expertenportal für Vasektomien


Harnblasen und Harnröhrenerkrankungen sowie Harninkontinenz


Erkrankungen des äußeren Genitales incl. Hodenund Peniserkrankungen


und

Zusatzbezeichnung Männerarzt durch das Institut cmi






Ludwigstraße 4 63739 Aschaffenburg
Telefon: 0 60 21 / 1 33 55
Fax: 0 60 21 / 21 90 01
info@dr-sawaya.de www.dr-sawaya.de


Die Zeit der Wechseljahre ist von gravierenden, hormonellen Veränderungen geprägt, die zahlreiche körperliche und psychische Symptome hervorrufen können. Bei der Linderung dieser Symptome spielt neben einer hormonellen Therapie die richtige Ernährung eine entscheidende Rolle und trägt mit dazu bei, das Risiko für begleitende Erkrankungen wie Osteoporose, Herz-KreislaufErkrankungen und Gewichtszunahme zu verringern.

Die Wechseljahre, die in der Regel zwischen dem 45. und 55. Lebensjahr beginnen, sind von einem Rückgang der weiblichen Geschlechtshormone, insbesondere Östrogen und Progesteron, begleitet. Diese hormonellen Veränderungen können eine Vielzahl von Symptomen verursachen, wie z B. Hitzewallungen, Schlafstörungen, Stimmungsschwankungen, Hautveränderungen und vaginaler Trockenheit. Langfristig können die Veränderungen auch das Risiko für Osteoporose, Herz-KreislaufErkrankungen und metabolische Störungen erhöhen.
Achtet man während der Wechseljahre auf die Ernährung, kann man Lebensqualität und Wohlbefinden jedoch wesentlich beeinflussen. Eine ausgewogene, nährstoffreiche Ernährung kann helfen, hormonelle Schwankungen auszugleichen, den Stoffwechsel zu stabilisieren und das Risiko für zahlreiche Erkrankungen zu verringern.
Hitzewallungen und schwankende Hormone
Hitzewallungen sind eines der häufigsten Symptome während der Wechseljahre. Eine ausgewogene Ernährung mit einem hohen Anteil an Phytoöstrogenen, die in pflanzlichen Lebensmitteln vorkommen, kann dabei helfen, das hormonelle Gleichgewicht zu stabilisieren. Phytoöstrogene sind pflanzliche Verbindungen, die eine ähnliche Struktur wie das menschliche Östrogen besitzen und somit eine östrogenähnliche Wirkung im Körper entfalten können. Gute Quellen für Phytoöstrogene sind Sojaprodukte (Tofu, Tempeh,
Besonders wichtig sind auch Ballaststoffe, die in Vollkornprodukten, Hülsenfrüchten, Obst und Gemüse enthalten sind. Sie tragen nicht nur zur Aufrechterhaltung eines gesunden Cholesterinspiegels bei, sondern unterstützen auch die Verdauung und regulieren den Blutzuckerspiegel, was wiederum das Risiko für Typ-2-Diabetes senkt.
Gewichtskontrolle und Stoffwechsel
Sojamilch), Leinsamen, Sesam und bestimmte Hülsenfrüchte.
Darüber hinaus sollten Frauen während der Wechseljahre auf eine ausreichende Zufuhr von Vitamin E achten, das antioxidative Eigenschaften hat und dabei hilft, den Körper vor oxidativem Stress zu schützen, der durch die hormonellen Veränderungen verstärkt auftreten kann. Vitamin E ist vor allem in pflanzlichen Ölen, Nüssen und Samen enthalten.
Knochenstärkung und Osteoporose-Prävention
Ein weiteres zentrales Thema in den Wechseljahren ist die Prävention von Osteoporose. Der Rückgang des Östrogenspiegels führt zu einer verminderten Knochendichte, was das Risiko für Knochenbrüche erhöht. Eine calciumreiche Ernährung ist daher von großer Bedeutung. Calcium wird in den Wechseljahren am besten durch Nahrungsmittel aufgenommen, die eine hohe Bioverfügbarkeit aufweisen, wie z B. grünes Blattgemüse (Brokkoli, Grünkohl), Nüsse, Samen und angereicherte pflanzliche Milchprodukte. Neben Calcium ist auch Vitamin D für die Knochengesundheit unerlässlich, da es die Aufnahme von Calcium im Darm fördert. Vitamin D kann durch Sonneneinstrahlung synthetisiert werden, jedoch reicht die natürliche Produktion häufig nicht aus, insbesondere in den Wintermonaten. Daher sollte auf eine ausreichende Zufuhr von Vitamin D aus der Nahrung (z B. fettreicher Fisch, angereicherte Lebensmittel) geachtet werden.
Herz-Kreislauf-Gesundheit und Cholesterinwerte
Der Rückgang des Östrogenspiegels in den Wechseljahren beeinflusst auch das HerzKreislaufsystem, da Östrogen eine schützende Wirkung auf die Blutgefäße hat. Dies kann zu einem Anstieg des Risikos für Herz-Kreislauf-Erkrankungen führen. Eine Ernährung, die reich an einfach ungesättigten und mehrfach ungesättigten Fettsäuren ist, kann helfen, das Risiko für Herzkrankheiten zu senken. Dazu zählen Lebensmittel wie Avocados, Olivenöl, Nüsse, Samen und fettreiche Fischarten wie Lachs, Forelle oder Makrele.
Die Veränderung des Hormonspiegels in den Wechseljahren kann auch zu einer Veränderung des Stoffwechsels führen, was häufig mit einer Zunahme von Körpergewicht und insbesondere Fettansammlungen im Bauchbereich einhergeht. Eine ballaststoffreiche Ernährung mit wenig Zucker und raffinierten Kohlenhydraten kann dabei helfen, Gewichtszunahme zu verhindern und den Blutzuckerspiegel stabil zu halten. Zudem spielt die ausreichende Versorgung mit hochwertigem Eiweiß eine wichtige Rolle, da es den Muskelabbau während der Wechseljahre verhindern kann. Quellen für pflanzliches Eiweiß sind Hülsenfrüchte, Nüsse, Samen und pflanzliche Proteinquellen wie Quinoa und Tofu. Auch pflanzliche Eiweißergänzungen können in Betracht gezogen werden, um eine ausreichende Versorgung zu gewährleisten.
Psychisches Wohlbefinden und Stimmungsschwankungen

Stimmungsschwankungen und emotionale Instabilität sind häufige Symptome der Wechseljahre, die durch die hormonellen Veränderungen verursacht werden. Eine ausgewogene Ernährung kann helfen, diese Symptome zu lindern. Insbesondere Omega-3-Fettsäuren, die in fettreichem Fisch und in Leinsamen, Walnüssen und Chiasamen enthalten sind, wirken entzündungshemmend und können dabei helfen, die Stimmung zu stabilisieren. Darüber hinaus kann der Verzehr von Lebensmitteln, die reich an B-Vitaminen sind – wie Vollkornprodukte, grünem Blattgemüse und Hülsenfrüchten – positive Auswirkungen auf das Nervensystem und die psychische Gesundheit haben.
Die Wechseljahre sind eine natürliche Übergangsphase im Leben einer Frau, die mit zahlreichen körperlichen und psychischen Veränderungen einhergeht. Eine ausgewogene Ernährung spielt eine zentrale Rolle, um diese Veränderungen zu unterstützen und die Lebensqualität zu erhalten. Durch die gezielte Zufuhr von Phytoöstrogenen, Calcium, Vitamin D, Omega-3-Fettsäuren und Ballaststoffen können viele der Wechseljahrsbeschwerden gemildert und das Risiko für langfristige gesundheitliche Probleme verringert werden. Eine individuell angepasste Ernährungsstrategie, die reich an frischen, unverarbeiteten Lebensmitteln ist, fördert nicht nur die körperliche Gesundheit, sondern auch das psychische Wohlbefinden während dieser Lebensphase.
Camargos Jensen Fachärztin für Frauenheilkunde und Geburtshilfe
Dr. Alexander Henze Facharzt für Frauenheilkunde und Geburtshilfe
und Geburtshilfe
● Vorsorge
● Intensivüberwachung während der Schwangerschaft: CTG, Farb-Doppler-Ultraschall, 2D-/3D-/4D-Ultraschall
● Hochau ösender Brustultraschall der Stufe II nach DEGUM
● Invenia ABUS 2.0, vollautomatischer 3D-Brustultraschall
● Ultraschallkontrollierte Mammastanzbiopsie
● Digitale Mammographie mit Tomosynthese
● Mammographiescreening
● Medikamentöse Tumortherapie
● Hormonsprechstunde
● Verhütungsberatung, Spiralen, Kupferkette
● Kinder-/Jugendgynäkologische Sprechstunde
● Akupunktur (A-Diplom)
● Ästhetische Medizin
– Faltenbehandlung mit Botox und Hyaluronsäure
– Lipolyse-Injektion (Fettweg-Spritze)
– Vitamin- und Wellnessinfusionen
– Botoxbehandlung bei verstärktem Schwitzen (Hyperhidrosis)
– Microneedling

FRAUENÄRZTE GESUNDHEITSZENTRUM ASCHAFFENBURG
Dr. Alexander Henze und Kolleginnen · Magnolienweg 12 • 63741 Aschaffenburg
Telefon: 0 60 21/444 77 3 0 · E-Mail: info@fagz.de · Internet: www.fagz.de
Die mediterrane Ernährung hat sich längst als eine der gesündesten Ernährungsformen etabliert – besonders, wenn es um die Gesundheit des Herzens geht. Zahlreiche wissenschaftliche Studien bestätigen, dass diese Ernährungsweise nicht nur das Risiko für Herz-Kreislauf-Erkrankungen reduziert, sondern auch zur allgemeinen Gesundheitsförderung beiträgt.

Grundlage der mediterranen Ernährung ist eine ausgewogene Mischung aus frischen, pflanzlichen Lebensmitteln, gesunden Fetten – kombiniert mit einer moderaten Zufuhr von tierischen Produkten. Sie fördert nicht nur das allgemeine Wohlbefinden, sondern trägt auch dazu bei, das Risiko von Herz-Kreislauf-Erkrankungen signifikant zu senken.
Ein zentrales Element der mediterranen Ernährung ist der hohe Anteil an pflanzlichen Lebensmitteln. Gemüse, Obst, Hülsenfrüchte, Vollkornprodukte und Nüsse stehen im Mittelpunkt. Diese Nahrungs-
mittel sind reich an Ballaststoffen, Vitaminen, Mineralstoffen und sekundären Pflanzenstoffen, die den Körper mit wichtigen Nährstoffen versorgen und entzündungshemmend wirken. Ein weiterer wichtiger Bestandteil sind gesunde Fette, insbesonders Olivenöl, das einen hohen Anteil an einfach ungesättigten Fettsäuren enthält. Diese Fettsäuren wirken positiv auf den Cholesterinspiegel und tragen dazu bei, das Risiko von Atherosklerose und anderen Herzkrankheiten zu verringern.
Fisch und Meeresfrüchte sind ebenfalls von zentraler Bedeutung, da sie reich an
Omega-3-Fettsäuren sind. Diese essenziellen Fettsäuren wirken entzündungshemmend, senken den Blutdruck und tragen zur Verbesserung der Blutfettwerte bei. Rotes Fleisch wird in der mediterranen Ernährung nur in Maßen konsumiert, wodurch der Anteil an gesättigten Fettsäuren niedrig gehalten wird – eine Maßnahme, die das Risiko für Herz-Kreislauf-Erkrankungen weiter minimiert.
Die Vorteile der mediterranen Ernährung sind umfassend belegt. Eine Langzeitstudie, die sogenannte „PREDIMED-Studie“, zeigte, dass Personen, die sich an diese Ernährungsweise hielten, ein um 30 Prozent reduziertes Risiko für kardiovaskuläre Ereignisse hatten. Auch die Sterblichkeit durch Herzkrankheiten und Schlaganfälle war signifikant niedriger.

Besonders hervorzuheben ist die Wirkung auf das Lipidprofil. Eine erhöhte Zufuhr von einfach ungesättigten Fettsäuren (z B. durch Olivenöl) und Omega3-Fettsäuren (aus Fisch) verbessert die Lipidwerte, indem sie das „gute“ HDLCholesterin erhöhen und das „schlechte“ LDL-Cholesterin senken. Zudem unterstützt die mediterrane Ernährung den Blutdruck und wirkt positiv auf die Insulinempfindlichkeit, was das Risiko für Typ2-Diabetes reduziert – ein weiterer Risikofaktor für Herz-Kreislauf-Erkrankungen.
Die mediterrane Ernährung ist mehr als nur ein Trend. Sie stellt eine nachhaltige Ernährungsweise dar, die nicht nur das Herz schützt, sondern auch das allgemeine Wohlbefinden fördert. Durch die Kombination von frischen Lebensmitteln, gesunden Fetten und moderatem Konsum tierischer Produkte können Patienten effektiv ihre kardiovaskuläre Gesundheit verbessern. Als präventive Maßnahme gegen Herz-Kreislauf-Erkrankungen ist die mediterrane Kost somit eine der besten Empfehlungen für Ärzte und Ernährungsberater.
Unsere Leistungen:
n Kardiologie
– Untersuchungen:
• Gespräch und körperliche Untersuchung
• Ruhe-EKG
• Belastungs-EKG
• Langzeit-EKG/Event-Recorder
• Langzeit-Blutdruckmessung
• Herzschrittmacher-/ Defibrillatorkontrolle
• Lungenfunktionsdiagnostik/ Ergospirometrie
• Herz-Ultraschalluntersuchung
• Cardio-MRT
• Cardio-CT
• Laboranalysen
– Schulungen/Weitere Leistungen
n Angiologie
– Untersuchungen:
• Gespräch und körperliche Untersuchung
• Gehstreckenbestimmung
• Gefäß-Ultraschalluntersuchung
n Sportmedizin
n Vorsorgeuntersuchungen
Kardiologische Gemeinschaftspraxis Aschaffenburg
Dr. med. Andreas Görz
Priv.-Doz. Dr. med. Werner Peters Fachärzte für Innere Medizin und Kardiologie
Hypertensiologie DHL® Sportmedizin
Stadtpalais Elisenstraße 32 Eingang A 63739 ASCHAFFENBURG

Die Physiotherapie ist darauf ausgerichtet, körperliche Beschwerden zu lindern und die Bewegungsfähigkeit der Patienten zu verbessern. Dass die Ernährung ein entscheidender Faktor für die Unterstützung von Heilungsprozessen und Muskelaufbau ist, rückt immer stärker in den Fokus.
Besonders nach Operationen, Verletzungen oder bei chronischen Erkrankungen ist der Wiederaufbau von Muskeln und Gewebe von zentraler Bedeutung. In der modernen Medizin und Physiotherapie rückt hierbei immer stärker in den Fokus, dass Gesundheit nicht nur durch Medikamente und therapeutische Maßnahmen erreicht wird, sondern auch durch eine ausgewogene Ernährung.
Physiotherapie lindert die körperlichen Beschwerden und verbessert die Bewegungsfähigkeit der Patienten. Während diese Maßnahmen oft auf die Rehabilitation von Verletzungen abzielen, ist die Ernährung zusätzlich ein entscheidender Faktor für die Unterstützung von Heilungsprozessen und Muskelaufbau. Besonders nach Operationen, Verletzungen oder bei chronischen Erkrankungen ist der Wiederaufbau von Muskeln und Gewebe von zentraler Bedeutung. Besonders wenn es um die Wiederherstellung der körperlichen Funktionsfähigkeit geht, spielt die Ernährung eine entscheidende Rolle. Sie unterstützt nicht nur die Heilung und Regeneration, sondern fördert auch den Muskelaufbau und kann zusätzlich Ängste vor einer Gewichtszunahme lindern.
Der Aufbau von Muskelmasse ist oft mit einer Erhöhung des Grundumsatzes verbunden, was langfristig zu einer besseren Fettverbrennung führt. Zwar wiegt Muskelgewebe mehr als Fettgewebe, d h. Die Zahl auf der Waage steigt zunächst, je-
doch ist die Veränderung der Körperzusammensetzung (mehr Muskelmasse, weniger Körperfett) wesentlich relevanter als die Zahl auf der Waage.
Ein gezielter Ernährungsplan, der auf den Bedarf des Körpers abgestimmt ist, sorgt dafür, dass der Muskelaufbau gefördert wird, ohne dass es zu einer übermäßigen Fettzunahme kommt. Hierbei spielt die Kalorienzufuhr eine wesentliche Rolle: Eine ausgewogene Kalorienzufuhr, die den Körper mit ausreichend Energie für den Muskelaufbau versorgt, aber nicht zu einer übermäßigen Ansammlung von Fett führt, ist entscheidend.
Eine gute Balance zwischen einer moderaten Kalorienzufuhr, ausreichend Protein und der richtigen Art von Kohlenhydraten (z B. komplexe Kohlenhydrate aus Vollkornprodukten, Obst und Gemüse) sorgt für eine nachhaltige Gewichtskontrolle.
Vor allem sportlich aktive Patienten benötigen zwar möglicherweise insgesamt weniger Kalorien als vor der Verletzung, sollten aber nicht so essen, als ob sie bewegungsarm wären. Ein Kalorienüberschuss bei einer Verletzung kann zu vermehrter Fetteinlagerung führen, eine unzureichende Kalorienaufnahme beschleunigt jedoch den Muskelabbau.
Während der Genesung von einer Verletzung des Bewegungsapparats ist der Nährstoffbedarf ähnlich hoch wie beim Muskelwachstum. Bei einer Verletzung oder
nach einer Operation kann der Körper zwischen 5 und 50 % mehr Kalorien pro Tag verbrennen. Der Stoffwechsel wird hochgefahren, um den Heilungsprozess zu unterstützen. Daher verlängert eine Beschränkung der Kalorienzufuhr den Rehabilitationsprozess und verringert auch die Proteinspeicher, was die Fähigkeit des Körpers, eine Verletzung zu reparieren, beeinträchtigt.
Proteinreiche Ernährung ist für den Muskelaufbau essenziell. Nach Verletzungen oder Operationen benötigt der Körper ausreichend Protein, um beschädigtes Gewebe zu reparieren und neues Muskelgewebe zu bilden. Dabei spielen nicht nur die Mengen an Protein eine Rolle, sondern auch die Qualität der Quelle. Hochwertige Eiweiße aus tierischen und pflanzlichen Quellen, wie mageres Fleisch, Fisch, Hülsenfrüchte oder Nüsse, sind besonders wichtig.
Ein weiterer wichtiger Aspekt der Ernährung in der Physiotherapie ist die Rolle bei Entzündungsprozessen. Chronische Entzündungen, etwa bei Erkrankungen wie Arthrose oder Tendinitis, können den Heilungsprozess verlangsamen und den Muskelaufbau beeinträchtigen. Eine entzündungshemmende Ernährung mit einem hohen Anteil an Omega-3-Fettsäuren (z B. aus fettreichem Fisch, Walnüssen und Leinsamen) kann dann dazu beitragen, den Schmerz zu lindern und die Muskulatur zu stärken. Antioxidative Lebensmittel (Beeren, grünes Blattgemüse und Nüsse) tragen ebenfalls dazu bei, freie Radikale zu neutralisieren und Entzündungen im Körper zu reduzieren.
Darüber hinaus ist es wichtig, auf eine ausreichende Flüssigkeitszufuhr zu achten, da Dehydrierung den Heilungsprozess und den Muskelaufbau hemmen kann. Wasser und Elektrolyte sind wichtig für die Funktion der Muskeln und Gelenke, da sie Muskelkrämpfe und eine verminderte Leistung verhindern.
Die Ernährung spielt eine zentrale Rolle in der Physiotherapie, insbesondere wenn es um die Förderung des Muskelaufbaus und die Unterstützung des Heilungsprozesses geht. Ein integrativer Ansatz, der Bewegung, Ernährung und psychologische Unterstützung kombiniert, ist der Schlüssel zu einer ganzheitlichen und nachhaltigen Heilung.
Praxis für …



Krankengymnastik kommt zum Einsatz bei Störungen bzw. Beschwerden des Bewegungsapparates, des Kreislaufs und der Atmung. Das Ziel ist die Wiederherstellung, Erhaltung oder Förderung der Gesundheit.
Therapeutische Anwendungen:
n Manuelle Therapie
n Bobath-Therapie
n Krankengymnastik
n Krankengymnastik am Gerät
n Manuelle Lymphdrainagen
n Klassische Massagen
n Schlingentisch
n Moorpackungen mit fossilem Mineralschlamm
Alle Anwendungen bieten wir Ihnen auch als Hausbesuche an!

In unserem Fitness- und Gesundheitsstudio können Sie unter individueller Anleitung hochqualifizierter Therapeuten an Chipkarten gesteuerten FitnessGeräten, Kardiogeräten, Seilzügen und Laufbändern trainieren.
Fitness- und Muskelaufbautraining:
n Aufbautraining
n Verbesserung der Kondition
n Galileo® Vibrationsplatte
n Sturzprophylaxe
Seit 44 Jahren sind mein Team und ich Ihre Partner für Physiotherapie in Aschaffenburg. Wir bieten Ihnen ein weitgefächertes Angebot an hochwertigen, qualifizierten Leistungen rund um Gesundheit und Wohlbefinden.
Öffnungszeiten unserer Praxis:
montags bis freitags von 8.00 bis 20.00 Uhr

Sie möchten sich verwöhnen lassen und dabei Ihre Gesundheit unterstützen? Sie möchten den Anforderungen des Alltags mit einem Lächeln begegnen? Sie möchten entspannen, abschalten, durchatmen und sich einfach wohlfühlen?
Unser Wohlfühl-Angebot:
n Kosmetik
n Fußpflege
n Handpflege
n professionelle Ganzkörpermassagen
n Kräuterstempelmassage
n Lymphdrainagen
n Fußreflexzonenmassage
n Enthaarungen mit Warmwachs
Gutscheine für jede Gelegenheit!




Der Weg zu einer gesünderen Gesellschaft führt über eine grundlegende Veränderung, die den Menschen in den Mittelpunkt stellt und die Verantwortung für die eigene Gesundheit wieder in die Hände der Menschen legt.
In einer Welt, in der Übergewicht und Adipositas auf dem Vormarsch sind, stellt sich eine grundlegende Frage: Warum verlieren wir zunehmend den Blick für die Bedeutung einer gesunden, natürlichen Ernährung? Die weltweite Ernährungsindustrie ist auf Profitmaximierung ausgerichtet. Hoch verarbeitete Lebensmittel, Fertiggerichte und Snacks dominieren den Markt und sind oft vermeintlich günstiger und bequemer zu konsumieren als frische, unverarbeitete Lebensmittel. Die Lebensmittelindustrie hat es geschafft, Zucker, Salz und ungesunde Fette in einem erschreckend hohen Maße in vielen Produkten zu integrieren. Das Ergebnis ist eine Gesellschaft, in der immer mehr Menschen zu ungesunden Lebensmitteln greifen, ohne sich der negativen Auswirkungen auf ihre Gesundheit bewusst zu sein.
Die Konsequenzen dieser Ernährung sind dramatisch: Übergewicht und Adipositas
stärkt und den Appetit zügelt. In der Öffentlichkeit, vor allem auch in den Medien, werden sie als einfache Lösung für Menschen mit Übergewicht und Adipositas gefeiert. Längst sind auf Social Media die sogenannten Ozempic-Faces populär: Prominente sind nach der Anwendung der Abnehm-Spritze Ozempic wegen ihrer durch die schnelle Abnahme eingefallenen Gesichter kaum wiederzuerkennen.
Die Abnehmspritzen können in bestimmten Fällen eine sinnvolle medizinische Option für Patienten mit schwerer Adipositas darstellen. Doch sie sind keineswegs eine Lösung für die breite Masse der Menschen, die mit Übergewicht zu kämpfen haben. Vielmehr müssen wir uns auf die wirklichen Ursachen konzentrieren, die in einer ungesunden Ernährung und mangelnder Bewegung liegen.
nehmen weltweit zu, was zu einer Zunahme von chronischen Erkrankungen wie Diabetes Typ 2, Herz-Kreislauf-Erkrankungen und Bluthochdruck führt. Diese Probleme sind keine Zufälle, sondern das Resultat eines Systems, das profitgetrieben ist und das Wohl der Menschen ignoriert. Statt gesunde, nahrhafte Lebensmittel zu fördern, werden Billigprodukte, die wenig Nährstoffe enthalten, massenhaft verkauft. Und so wird die Gesundheit der Menschen zugunsten von Unternehmensgewinnen aufs Spiel gesetzt.
Stattdessen erleben wir in der heutigen Zeit eine zunehmende Kommerzialisierung des Essens, bei der schnelle Lösungen wie die Abnehmspritze als Allheilmittel verkauft werden. Inmitten dieser Entwicklung sind Abnehmspritzen als „Wunderwaffen“ gegen Übergewicht populär geworden. Sie versprechen eine schnelle Gewichtsreduktion durch eine einfache Injektion, die das Sättigungsgefühl ver-
Was wir wirklich brauchen, ist eine Ernährungswende, die den Fokus auf die Gesundheit und das Wohl der Menschen legt und nicht auf die Profite von Konzernen. Es geht darum, den Menschen wieder beizubringen, wie wichtig es ist, sich gesund zu ernähren, und dabei frische, unverarbeitete Lebensmittel zu bevorzugen. Eine gesunde Ernährung besteht nicht aus Diäten oder schnellen Lösungen, sondern aus einer ausgewogenen Zufuhr von Nährstoffen, die der Körper für ein optimales Funktionieren benötigt. Doch die Veränderung muss nicht nur auf individueller Ebene stattfinden. Wir müssen auch die gesellschaftliche und wirtschaftliche Ebene einbeziehen. Es ist an der Zeit, dass wir die Gesundheit der Menschen in den Mittelpunkt stellen. Ein System, das die Gesundheit fördert, statt sie zu gefährden, würde auf die Bereitstellung von Nahrungsmitteln abzielen, die dem Körper gut tun und die Umwelt schonen. Lebensmittel müssten in erster Linie den Bedürfnissen der Menschen entsprechen und nicht den Gewinninteressen von Konzernen. Nur so können wir Übergewicht, Adipositas und die damit verbundenen Krankheiten langfristig bekämpfen und die Lebensqualität der Menschen nachhaltig verbessern.


Unser Leistungsspektrum – Ihre Vorteile:
n Kundenfreundliche Öffnungszeiten
n Schließfachservice für Abholungen außerhalb der Öffnungszeiten
n Botendienst
n Mehrsprachiges Fachpersonal (Englisch, Französisch, Italienisch, Türkisch und Russisch)
n Monatlich wechselnde Sonderangebote
n Gesundheits-Checks
n Blutdruckmessungen
n Fernreise- und Impfberatung
n Stadelmann-Produkte
n Ernährungsberatung
„Für ein besonders diskretes Gespräch steht Ihnen unser separater Beratungsraum zur Verfügung! Sprechen Sie uns vertrauensvoll an!“
n Verleih von Medela-Milchpumpen und Babywaagen
n Anpassen von Kompressionsstrümpfen
n Kundenkarte mit vielen Vorteilen
n Erstellung von Jahresrechnungen zur Vorlage bei Krankenkasse und Finanzamt
Dr. Tobias Craan e.K. Ludwigstraße 2 (am Hauptbahnhof) 63739 Aschaffenburg
Telefon:
email: info@bahnhof-apotheke.biz www.bahnhof-apotheke.biz
ÖFFNUNGSZEITEN:
Montag bis Freitag von 08:00 bis 19:00 Uhr Samstag von 08:30 bis 14:00 Uhr
… oder nutzen Sie unsere Abholfächer und unseren Lieferservice am Ausgang Richtung Stadtmitte

Die Gesundheit unserer Leber ist eng mit unserer Ernährung verknüpft. Eine Fettleber, medizinisch als nicht-alkoholische Fettlebererkrankung (NAFLD) bezeichnet, entsteht, wenn sich übermäßig Fett in der Leber ansammelt. Dies

Wie entsteht eine Fettleber?
Die Leber ist das Stoffwechselzentrum unseres Körpers. Sie verarbeitet Nährstoffe, baut Giftstoffe ab und speichert Energie in Form von Fett. Wird jedoch mehr Energie aufgenommen, als der Körper benötigt, wird das überschüssige Fett in der Leber gespeichert wodurch sich die Leber vergrößert. Eine Ernährung mit vielen gesättigten Fettsäuren, Zucker (insbesondere Fruktose) und stark verarbeiteten Lebensmitteln begünstigt diesen Prozess. Auch Softdrinks und industriell hergestellte Süßigkeiten sind häufige Auslöser. Besonders gefährlich ist dies in Kombination mit Übergewicht und Insulinresistenz – einer Vorstufe von Diabetes. In diesem Zustand kann die Leber das eingelagerte Fett nicht mehr effizient abbauen, was die Entstehung einer Fettleber zusätzlich beschleunigt.
Auch regelmäßiger, zu hoher Alkoholkonsum kann zu einer Leberverfettung führen und wird dann als alkoholische Fettlebererkrankung bezeichnet (AFLD).
Unabhängig von Ernährungsfaktoren und Alkohol kann eine Fettleber aber auch bei verschiedenen Erkrankungen auftreten, wie z B. bei einer Hepatitis C, einer Hämochromatose, einem M. Wilson, einer Zöliakie, einer chronisch entzündlichen Darmerkrankung oder bei Fettstoffwechselstörungen.
Fettleberzirrhose: Das Endstadium
Wird die Fettleber über Jahre nicht behandelt, kann es zu einer Fettleberentzündung (Fettleberhepatitis, NASH) kommen. Diese chronische Reizung führt zunächst zu einer Vermehrung des Bindegewebes in der Leber (Leberfibrose). Wenn der Entzündungsprozess weiter anhält, kommt es zur Vernarbung des Lebergewebes, einer sogenannten Leberzirrhose. Bei einer Leberzirrhose ist die Funktion der Leber stark eingeschränkt, da das vernarbte Gewebe die gesunden Leberzellen verdrängt. Dies kann zu lebensgefährlichen Komplikationen wie Leberversagen oder Leberkrebs führen.
Wie kann man eine Fettleber diagnostizieren?
Die Diagnose einer Fettleber erfolgt in der Regel durch eine Kombination aus Anamnese, körperlicher Untersuchung, Laboruntersuchungen und bildgebenden Verfahren.
1. Anamnese
Der Arzt erfragt die Krankengeschichte, um mögliche Risikofaktoren für eine Fettleber zu identifizieren. Wichtige Punkte sind dabei Ernährungsgewohnheiten, Alkoholkonsum, Vorliegen von Übergewicht und Erkrankungen wie Diabetes mellitus Typ 2, Insulinresistenz oder Bluthochdruck. Auch Medikamente können die Leber belasten
und daher muss deren Einnahme erfragt werden. Da etwa 20 % der Patienten mit Fettleber nicht übergewichtig sind, kann auch bei Menschen mit normalem Körpergewicht eine Verfettung der Leber bestehen.
2. Körperliche Untersuchung
Der Arzt prüft durch Abtasten die Größe der Leber. Zeichen einer fortgeschrittenen Lebererkrankung sind Gelbsucht, Hautveränderungen oder Einlagerung von Bauchwasser.
3. Blutuntersuchungen
Blutwerte helfen, die Funktion der Leber zu beurteilen und eine Fettleber zu vermuten. Erhöhte Leberwerte (Transaminasen, alkalische Phosphatase, Bilirubin) oder auch erniedrigte Werte (Cholinesterase, Eiweiß, Quick) können auf eine vermehrte Belastung oder eine Schädigung der Leber hinweisen. Erhöhte Blutfette (Cholesterin und Triglyzeride) können Begleiter einer Fettleber sein. Blutzucker und HbA1c geben Hinweise auf Insulinresistenz oder Diabetes, was häufig mit einer Fettleber assoziiert ist.
4. Bildgebende Verfahren
Bei der konventionellen Ultraschalluntersuchung (Sonographie) des Bauches kann der Verdacht auf eine Leberverfettung geäußert werden. Eine ausgeprägte Fettleber zeigt sich hier durch ein „helleres“ Bild des Lebergewebes aufgrund des hohen Fettgehaltes. Frühe Formen der Fetteinlagerung in der Leber können jedoch nicht sicher diagnostiziert werden. Magnetresonanztomographie (MRT) oder Computertomographie (CT) werden zur primären Diagnostik einer Fettleber seltener eingesetzt, ermöglichen aber auch eine Darstellung des Fettgehalts der Leber und insbesondere der Leberzirrhose und ihrer Komplikationen.
5. Ultraschallmessungen Mit einer speziellen Ultraschallmethode können schnell und komplikationslos unterschiedliche Verfettungsgrade der Leber (S0 – S4) zuverlässig gemessen werden. Zudem kann in der gleichen Untersuchung mittels Elastographie (Messung der Steifigkeit des Lebergewebes) eine Aussage gemacht werden, ob und in welchem Ausmaß schon ein bindegewebiger Umbau der Leber (Fibrose oder Zirrhose) stattgefunden hat. Aus den Daten lassen sich auch

Ultraschalluntersuchung zur Bestimmung des Fettgehaltes und des Fibrosegrades der Leber.
6. Leberbiopsie n unklaren Fällen oder bei Verdacht auf eine fortgeschrittene Leberschädigung kann die Entnahme einer Gewebeprobe aus der Leber notwendig sein. Sie erlaubt eine exakte Diagnose verschiedener Lebererkrankungen und kann auch sicher zwischen einer einfachen Fettleber und einer entzündlichen Fettleber unterscheiden. Aufgrund der zuvor genannten diagnostischen Möglichkeiten ist eine Leberbiopsie aber nur selten notwendig.
Gibt es medikamentöse Therapieoptionen?
Ein erstes Medikament zur Behandlung der Fettleberhepatitis ist seit 2024 in den USA verfügbar. Leider ist dieses Präparat derzeit nicht in Deutschland zugelassen, so dass die Umstellung der Ernährung die wichtigste Maßnahme bleibt.
Wie kann Ernährung helfen?
FÜR IHRE GESUNDHEIT.
Hinweise auf bereits bestehende Komplikationen einer Leberzirrhose, wie z B. Ösophagusvarizen, ableiten. Diese Ultraschallmessungen sind ein wichtiges Hilfsmittel bei der Diagnostik und der Verlaufsbeurteilung von Lebererkrankungen, die mit einer Fetteinlagerung oder einem bindegewebigem Umbau einhergehen. Auch andere Leberkrankheiten, die ohne Verfettung zu einer Leberfibrose führen (z B. PBC, PSC oder autoimmune Hepatitis), können mit dieser Methode beurteilt werden, um die eingesetzten Medikamente entsprechend anzupassen.
Gesundheit und Wohlbefi nden unserer Patienten stehen an erster Stelle. Und wir setzen uns für dieses Ziel ein. Mit erem breiten Spektrum medizinischer Leistungen und einem hochqualifi zierten Team an Ärzten sind wir die Experten für gastroenterologische Erkrankungen Nicht nur zentral im Herzen Aschaffenburgs, sondern vor allem immer nah am Patienten.
Die Ernährung hat einen entscheidenden Einfluss auf die Gesundheit der Leber. Mit einer ausgewogenen, leberfreundlichen Ernährung und ausreichend Bewegung lassen sich Fettleber und ihre schwerwiegenden Folgen in vielen Fällen vermeiden. Es ohnt sich also, insbesondere frühe Formen der Leberveränderungen zu diagnostizieren und rechtzeitig Gegenmaßnahmen zu ergreifen, um Komplikationen zu verhindern.
IHR TEAM DER GASTROENTEROLOGISCHEN GEMEINSCHAFTSPRAXIS ASCHAFFENBURG
Die gute Nachricht: Eine Fettleber kann sich meist zurückbilden, besonders in frühen Stadien. Eine Umstellung der Ernährung spielt dabei die entscheidende Rolle: Zucker vermeiden – vor allem Fruktose und raffinierter Zucker sollten reduziert werden. Ernährung mit vollwertiger Kost – frisches Obst, Gemüse, Vollkornprodukte und Hülsenfrüchte unterstützen die Lebergesundheit. Gesunde Fette bevorzugen – ungesättigte Fettsäuren aus Nüssen, Avocado und Fisch sind förderlich. Gewichtsreduktion anstreben: Bereits eine Gewichtsabnahme von 5 – 10 % kann eine Fettleber signifikant reduzieren. Auch die Vermeidung lebertoxischer Substanzen (einschließlich Alkohol) unterstützt die Rückbildung einer Leberverfettung.
Sollte aufgrund von Risikofaktoren, Laborveränderungen oder Untersuchungsbefunden der Verdacht auf eine Leberverfettung oder bereits eine Leberfibrose bestehen, ist die Durchführung einer speziellen Ultraschallmessung der Leber (Fibroscan) zu empfehlen. Gerne kann dazu ein Termin in unserer Praxis vereinbart werden.
Prof. Dr. med. W. Fischbach, Priv.-Doz. Dr. med. R. Melcher, Dr. med. C. Noé, Priv.-Doz. Dr. med. H. Lührs, Dr. med. K. Metz, Dr. med. O. Tabarelli
IHR TEAM DER GASTROENTEROLOGISCHEN GEMEINSCHAFTSPRAXIS ASCHAFFENBURG
Prof. Dr. med. W. Fischbach, Priv.-Doz. Dr. med. R. Melcher, Dr. med. C. Noé, Priv.-Doz. Dr. med. H. Lührs, Dr. med. K. Metz, Dr. med. O.



Nach aktuellen Schätzungen atmen etwa 50– 60 % der Kinder hauptsächlich durch den Mund. Es gibt nur wenige Kinder, die ein fehlerfreies Gebiss haben. Studien zeigen, dass 70– 80 % der Zahn- und Kieferfehlstellungen nicht genetisch bedingt sind, sondern durch Umwelteinflüsse verursacht oder mitverursacht werden, wie Lutschgewohnheiten, veränderte Haltung und Ernährung.
Wenn die Muskeln im Gesicht und Mund nicht richtig funktionieren, kann das Probleme beim Atmen, Schlucken, Kauen und Sprechen verursachen. Ärzte und Therapeuten sprechen dann von einer myofunktionellen Störung (MFS) oder orofazialen Dysfunktion (OFD). Diese Entwicklungsstörungen beeinträchtigen die primären und sekundären oralen Funktionen und betreffen den Mundraum, das Gebiss, die Nase, Hör- und Riechfähigkeit, Sprachentwicklung, das Gesicht, den Körper und die Verdauung.
Einfluss der Umwelt auf die Mundgesundheit
Kinder sind täglich zahlreichen Umweltfaktoren ausgesetzt, die ihre Mundgesundheit beeinflussen können, z B.:
n Ungünstige Flaschensauger: Gängige Sauger weichen oft von der Mutterbrust ab. Das Lippenschild hat einen
zu kleinen Durchmesser, das Loch ist zu groß. Die Zunge schiebt nach vorne, Zungen-, Lippen- und Gesichtsmuskulatur werden nicht trainiert.
n Lutschgewohnheiten: Daumenlutschen oder zu langes Schnullen (> als 2,5 oder 3 Jahre) führen oft zu Zahnund Kieferfehlstellungen.
n Haltungsveränderungen: Schlechte Körperhaltung kann die Atmung und die Entwicklung des Gesichts- und Mundbereichs negativ beeinflussen.
n Veränderte Ernährung: Eine Ernährung, die weiche und verarbeitete Lebensmittel bevorzugt, kann dazu führen, dass die Kau- und Schluckmuskulatur nicht ausreichend trainiert wird.
Babys atmen in den ersten Lebensmonaten hauptsächlich durch die Nase. Die Fähigkeit durch den Mund zu atmen, entwickeln sie erst ab dem Alter von etwa
Gaumen eine notwendige Dehnung und Weitung des Kiefers und oberen Gaumens ergibt, damit später alle Zähne Platz haben. Beim Stillen werden Lippen, ein guter Mundschluss und die Zunge in idealer Weise trainiert, auch der Unterkiefer entwickelt sich besser. Stillen an der Mutterbrust ist deshalb auch für die Entwicklung der Mund-, Gaumen-, Kiefer-, Zungen- und Schluckfunktion die beste Voraussetzung
Mundatmung und mögliche Auswirkungen auf das Gebiss
– Kreuzbiss; hoher, gotischer Gaumen, Unterkiefer größer als der Oberkiefer
– Frontal oder/und lateral offener Biss, stark vergrößerte sagittale Stufe, Engstände der Zähne
Mundatmung und mögliche Auswirkungen auf den Körper
– müder Gesichtsausdruck, blasse Gesichtsfarbe, Augenringe (Übermüdung)
Funktion gemeinsam zu behandeln. Sie muss patientenindividuell und interdisziplinär erfolgen. Dabei sollten Kinderärzte, Zahnärzte, HNO-Ärzte, Kieferorthopäden und MFT-Sprachtherapeuten eng zusammenarbeiten. Die Entwöhnung von Lutschgewohnheiten, der Lippenschluss, die richtige Zungenruhelage am Gaumen und die Nasenatmung sind dabei die wichtigsten Therapieziele. Die gute Nachricht: Eine Therapie ist auch noch im Erwachsenenalter möglich.
3 bis 4 Monaten. Die physiologische Atmung ist die Nasenatmung. Dank der Nase können wir mit geschlossenem Mund atmen.
Stillen hat viele Vorteile
Beim Stillen an der Mutterbrust lernt das Baby bereits wichtige Funktionen. Es schluckt zunächst so, wie es später nicht mehr schlucken soll. Es schiebt die Zunge nach vorne zwischen die Zähne. Durch das tägliche mehrmalige über mindestens sechs Monate fortwährende Stillen prägt sich das Baby ein Schlucken ein, das es später dringend braucht:
Das Schlucken gegen den Gaumen Das ist besonders wichtig, da sich durch die vielen Schluckvorgänge gegen den

Die offene Mundhaltung ist der Anfang der meisten myofunktionellen Störungen. Die gesamte orofaziale Muskulatur ist hier nicht im Gleichgewicht. Alle Muskelgruppen arbeiten normalerweise synergetisch zusammen. Wenn eine Funktion nicht physiologisch arbeitet, werden alle andern geschwächt. Wenn Babys oder Kleinkinder mit offenem Mund schlafen und auch tagsüber immer wieder der Mund offensteht, sollte man dies genau beobachten. Neben vergrößerten Rachenmandeln, unterentwickelten Nasenhöhlen und Allergien sind in den meisten Fällen ein Ungleichgewicht zwischen den Muskelgruppen im Gesicht, Lippen, Mundmuskeln und Zungenmuskel die Ursache. Der beim Lippenkontakt entstehende Unterdruck ermöglicht es der Zunge, ihre physiologische Lage am Gaumen einzunehmen. Bleibt die Zunge am Mundboden liegen, hat dies weitreichende Auswirkungen. Die größten negativen Auswirkungen entstehen besonders in Ruhe, d.h. vor allem nachts
Infos
Myofunktionelle Störungen
– fehlende Nasenatmung und fehlender Mundschluss (offene Mundhaltung)
– Fehlfunktionen der Zunge (falsche Zungenruhelage, falsches Schluckmuster, gestörte Kaufunktion)
– phonetische Artikulationsstörung (fehlerhafte Bildung der Laute /S/ und /SCH/)
Mundatmung und mögliche intraorale Auswirkungen
– signifikant mehr Karies; vermehrt Zahnstein, Entmineralisierungen, weiße Flecken
– vermehrte Zahnfleischentzündungen, geröteter Rachenring, stark vergrößerte Tonsillen, unwillkürlicher Speichelverlust
– Atemwegserkrankungen, verkleinertes Mittelgesicht, verkleinerte Nasengänge
– Unbeweglichkeit der Nasenflügel, Unbeweglichkeit der Oberlippe
– geschwächte Körperhaltung (Sauerstoffmangel), Konzentrationsprobleme (Sauerstoffmangel)
– Schlafprobleme (unruhiges Schlafen), Schnarchen
– rezidivierende Mittelohrentzündungen
Mundatmung und mögliche Auswirkungen auf die Verdauung
– Das Zwerchfell arbeitet nicht optimal
– Der Stoffwechsel wird nicht genügend angeregt
– Die Enzyme des Speichels werden durch Sauerstoff verändert und können ihre Aufgabe nicht gut erfüllen.
Mundatmung und mögliche Auswirkungen auf den HNO-Bereich
– ungenügend belüftete Eustachische Röhre, Tubenfunktionsstörung, chronischer Schnupfen
– verminderte Hörfähigkeit, Sprachprobleme, verzögerte Sprachentwicklung
– trockene, verkrustete Nasenschleimhäute, verminderte Riechfähigkeit
Sabine Fuhlbrück, Zahnmedizin; Dr. Freudenberger, myofunktionelle, ganzheitliche Kieferorthopädie
Eltern können viel dafür tun, die Entwicklung der oralen Funktionen bei ihren Kindern zu fördern. In den ersten Lebensjahren ist es wichtig, dass Kinder durch die Nase atmen, richtig saugen, mit ihrem Essen experimentieren, gründlich kauen und richtig schlucken. Diese Dinge helfen dabei, dass ihre Muskeln und ihr Körper sich gut entwickeln.
Ziel einer effektiven myofunktionellen Therapie sollte es immer sein, Form und

Dr. phil. Ingeborg Maser Neurolinguistin, Klinische Linguistin dbl/dbs

Akademische Praxis für Sprachtherapie
Insbesondere Tabletten mit Lutein für die Makuladegeneration und auch zunehmend für den Grünen Star/Glaukom gibt es von von zahlreichen Firmen. Produkte, die allerdings teuer sind, nichts bringen und gesundheitliche Risiken mit sich bringen können.

Die Makuladegeneration (AMD), eine der häufigsten Ursachen für schwerwiegende Sehstörungen im Alter, betrifft vor allem den zentralen Bereich der Netzhaut, der für das scharfe Sehen verantwortlich ist. Während viele Patienten nach Nahrungsergänzungsmitteln wie Lutein-haltigen Produkten suchen, gibt es zunehmend Hinweise darauf, dass deren Wirkung in der Prävention und Behandlung der Erkrankung begrenzt ist. Stattdessen sind eine ausgewogene Ernährung, der Verzicht auf Rauchen und moderate körperliche Aktivität nachweislich effektive Maßnahmen zur Förderung der Augengesundheit.
nes einzelnen Nährstoffs. Insbesondere eine abwechslungsreiche Ernährung, die viel Obst, Gemüse, Vollkornprodukte und gesunde Fette enthält, trägt zur allgemeinen Gesundheit und damit zur Aufrechterhaltung der Augengesundheit bei. In diesem Zusammenhang spielen auch der Verzicht auf Rauchen und moderate körperliche Aktivität eine entscheidende Rolle.
Rauchen ist ein bekannter Risikofaktor für die Entwicklung der Makuladegeneration und kann den Verlauf der Erkrankung erheblich verschlechtern. Darüber hinaus wurde nachgewiesen, dass regelmäßige körperliche Aktivität das Risiko für viele chronische Erkrankungen, einschließlich AMD, reduziert und die allgemeine Gesundheit der Augen positiv beeinflusst.
In fortgeschrittenen Stadien der Makuladegeneration, insbesondere bei der feuchten Form der Erkrankung, bei der es zu unerwünschten Gefäßneubildungen unter der Netzhaut kommt, ist eine medikamentöse Therapie notwendig. Die sogenannte intravitreale operative Medikamentengabe (IVOM) hat sich hier als äußerst erfolgreich erwiesen. Bei dieser Behandlung wird ein Medikament direkt in den Glaskörperraum des Auges injiziert, um das Fortschreiten der Erkrankung zu stoppen oder zu verlangsamen. Durch IVOM können Patienten mit feuchter Makuladegeneration ihre Sehkraft häufig stabilisieren oder sogar verbessern.

Wissenschaftler betonen, dass die Kombination von Antioxidantien, Vitaminen, Mineralstoffen sowie Omega-3-Fettsäuren aus natürlichen Quellen weitaus wirksamer ist als die alleinige Einnahme ei-
Lutein und Zeaxanthin sind Carotinoide, die in verschiedenen Lebensmitteln vorkommen, insbesondere in grünem Blattgemüse wie Spinat und Grünkohl, sowie in Eigelb und einigen Obstsorten. Diese Stoffe gelten als Antioxidantien und werden oft mit einer verbesserten Augengesundheit in Verbindung gebracht. Es gibt zahlreiche Nahrungsergänzungsmittel, die hohe Mengen an Lutein enthalten, und viele Patienten erhoffen sich von deren Einnahme einen positiven Effekt auf die Prävention der AMD. Jedoch zeigen aktuelle wissenschaftliche Studien, dass Lutein allein keine signifikante Wirkung auf das Fortschreiten der Erkrankung hat. Die klinische Forschung hat die Wirkung von Lutein und anderen Nahrungsergänzungsmitteln zwar umfassend untersucht, aber es gab keine belastbaren Beweise, die bestätigen, dass die Einnahme von Lutein-haltigen Produkten das Risiko einer Makuladegeneration signifikant verringern kann. Vielmehr wurde festgestellt, dass eine ausgewogene Ernährung mit einer Vielzahl an Vitaminen und Mineralstoffen, wie sie in einer gesunden Ernährung vorkommen, einen deutlich positiven Einfluss auf die Augen hat.
Zusammenfassend lässt sich sagen, dass Lutein-haltige Produkte alleine keine ausreichende Wirkung bei der Prävention oder Behandlung der Makuladegeneration bieten. Eine gesunde Lebensweise mit ausgewogener Ernährung, Nichtrauchen und regelmäßigem Sport bleibt die beste Empfehlung zur Förderung der Augengesundheit. In fortgeschrittenen Fällen steht mit der IVOM eine effektive therapeutische Option zur Verfügung, die vielen Patienten hilft, ihre Sehkraft zu erhalten und die Lebensqualität zu verbessern.
Daher bieten wir Ihnen in den ReVis Augenzentren das gesamte Spektrum der konservativen und operativen Augenheilkunde an, von Vorsorgeuntersuchungen über die Therapie von Augenerkrankungen bis hin zur modernen Laserkorrektur.
Daher bieten wir Ihnen in der ReVis Augenklinik das gesamte Spektrum der konservativen und operativen Augenheilkunde an, von Vorsorgeuntersuchungen über die Therapie von Augenerkrankungen bis hin zur modernen Laserkorrektur.
Erfahren Sie mehr über die ReVis Augenklinik auf:
Erfahren Sie mehr über die ReVis Augenzentren auf.
www.revis.de
In den letzten Jahren hat sich der Trend hin zu einer gesunden Ernährung verstärkt, und nicht nur der Körper profitiert davon – auch die Zähne können von einer bewussten Nahrungsaufnahme maßgeblich profitieren.

Unsere Zähne sind täglich verschiedenen Herausforderungen ausgesetzt: Zuckerhaltige Nahrungsmittel, Säuren aus Obst und Getränken sowie die Beläge von Bakterien können die Zahngesundheit langfristig beeinträchtigen. Eine ausgewogene Ernährung ist daher nicht nur für die allgemeine Gesundheit, sondern auch für die Zahnpflege von großer Bedeutung.
Zu den entscheidenden Nährstoffen für die Zahngesundheit zählen insbesondere Calcium, Phosphor, Vitamin D und Vitamin C. Calcium stärkt den Zahnschmelz, der als natürliche Schutzbarriere für die Zähne fungiert. Phosphor wirkt in Zusammenarbeit mit Calcium und hilft dabei, die Zähne zu remineralisieren. Vitamin D unterstützt die Aufnahme von Calcium und Phosphor, was die Festigkeit der Zähne unterstützt – fehlt Vitamin D, kann das die Heilung nach chirurgischen Eingriffen oder parodontalen Behandlungen negativ beeinflussen. Vitamin C spielt eine Rolle bei der Gesunderhaltung des Zahnfleisches und der Unterstützung des Immunsystems, was Entzündungen und Infektionen vorbeugt.
Ein wesentlicher Faktor, der oft zu Zahnschäden führt, ist der hohe Konsum von Zucker und säurehaltigen Lebensmitteln. Zucker wird von den Bakterien im Mund in Säuren umgewandelt, die den Zahnschmelz angreifen und Karies begünstigen können. Darüber hinaus führen säurehaltige Lebensmittel wie Zitrusfrüchte, Limonade oder auch Wein dazu, dass der Zahnschmelz weich wird und somit anfälliger für Abrieb ist.
Wer auf seine Zahngesundheit achtet, sollte den übermäßigen Verzehr von Zucker und säurehaltigen Nahrungsmitteln möglichst einschränken und stattdessen zu gesunden Alternativen greifen. Besonders empfehlenswert sind Vollkornprodukte, grünes Blattgemüse, Nüsse, Hülsenfrüchte und fettreiche Fische wie Lachs. Diese liefern nicht nur die benötigten Nährstoffe, sondern fördern auch die Speichelproduktion, die dabei hilft, Säuren und Zucker aus dem Mund zu spülen.
Nach dem FOCUS-RANKING 2024 zum 16. Mal in Folge unter den besten Implantologen Deutschlands.*
In den letzten Jahren sind sogenannte „Superfoods“ in den Fokus gerückt, die nicht nur das allgemeine Wohlbefinden fördern, sondern auch für gesunde Zähne von Vorteil sind. Lebensmittel wie grüner Tee, Karotten, Äpfel oder Sellerie wirken auf natürliche Weise reinigend und unterstützen die Remineralisierung des Zahnschmelzes. Grüner Tee enthält Antioxidantien, die Entzündungen im Mundraum vorbeugen können, während Äpfel und Karotten durch ihre feste Textur eine mechanische Reinigung der Zähne unterstützen und die Produktion von Speichel anregen.
Neben der Wahl der richtigen Lebensmittel spielt auch der Zeitpunkt des Verzehrs eine Rolle. Wer direkt nach den Mahlzeiten seine Zähne putzt, kann den Zahnschmelz unnötig schädigen, besonders nach dem Verzehr von sauren Nahrungsmitteln. Experten empfehlen, mindestens 30 Minuten zu warten, bevor man zum Zahnbürstchen greift. Besser ist es, nach den Mahlzeiten zunächst mit Wasser oder ungesüßtem Tee zu spülen und den Speichel seine natürliche Arbeit tun zu lassen. So lässt sich auch Obstsäure am besten neutralisieren.‚
Gesunde Ernährung ist längst nicht mehr nur ein Trend, der den Körper fitter macht, sondern hat auch positive Auswirkungen auf die Zahngesundheit und damit auf die äußere Erscheinung. Die richtige Ernährung kann dabei helfen, Zähne zu stärken, Zahnfleischentzündungen vorzubeugen und die allgemeine Mundgesundheit zu fördern. So wird eine ausgewogene Ernährung zu einem wichtigen Bestandteil der täglichen BeautyRoutine – für strahlend schöne Zähne und ein gesundes Lächeln.


Schmerzen im Knie oder Sprunggelenk werden häufig als isolierte Beschwerden betrachtet. Allerdings können diese Schmerzen auch mit Problemen in den Füßen zusammenhängen. Viele Patienten wissen oft nicht, dass Fußprobleme wie Fehlstellungen, Überlastungen oder Verletzungen auch Auswirkungen auf andere Gelenke im Körper haben können. Besonders das Knie- und Sprunggelenk sind häufig betroffen, da sie direkt mit der Fußmechanik verbunden sind. In diesem Artikel erläutern wir, wie Fußprobleme Schmerzen in diesen Gelenken verursachen können und was Patienten tun können, um diese Beschwerden zu lindern.
Die Anatomie von Fuß, Knie und Sprunggelenk
Der menschliche Fuß ist ein komplexes Konstrukt, das aus 26 Knochen, zahlreichen Bändern, Sehnen und Muskeln besteht. Seine Funktion besteht vor allem darin, den Körper bei der Fortbewegung zu stützen und abzupuffern. Ein richtig funktionierender Fuß sorgt dafür, dass das Körpergewicht gleichmäßig auf den Boden übertragen wird. Das Sprunggelenk verbindet den Fuß mit dem Unterschenkel und ist für das Heben und Senken des Fußes verantwortlich. Es ermöglicht Bewegungen wie das Abrollen und Aufsetzen des Fußes während des Gehens oder Laufens. Das Kniegelenk wiederum verbindet den Oberschenkel mit dem Unterschenkel und spielt eine entscheidende Rolle bei der Stabilität und dem Bewegungsspielraum der unteren Extremitäten. Durch die enge Verbindung
dieser Gelenke und ihre koordinierte Bewegung ist es nicht überraschend, dass Probleme im Fußbereich auch Auswirkungen auf Knie und Sprunggelenk haben können.
Fußfehlstellungen und ihre Auswirkungen auf das Knie und Sprunggelenk
Ein häufiges Beispiel für eine Fußfehlstellung ist der sogenannte „Plattfuß“ (Pes planus), bei dem das Fußgewölbe abgeflacht ist. Dies führt dazu, dass der Fuß beim Gehen oder Laufen weniger Stabilität bietet. Infolgedessen verändert sich die gesamte Körpermechanik, und der Fuß kann übermäßig pronieren, also nach innen kippen. Diese Fehlstellung kann eine unnatürliche Belastung auf das Sprunggelenk und das Knie ausüben, was langfristig zu Schmerzen und Problemen führen kann.
Hallux Rigidus) wegen der dort auftretenden Schmerzen zu einer veränderten Fußstellung beim Laufen. Kompensiert wird diese Fehlstellung im Fuß durch eine veränderte Gelenkstellung im Sprungund Kniegelenk, weshalb dann dort durch die Überbelastung Schmerzen auftreten können.
Behandlung und Prävention

Ein weiteres Beispiel ist der „Hohlfuß“ (Pes cavus), bei dem das Fußgewölbe zu stark ausgeprägt ist. Auch hier kommt es zu einer ungleichmäßigen Druckverteilung, die die Gelenke des Sprunggelenks und Knies zusätzlich belastet. Diese Fehlstellungen erhöhen das Risiko für die Entwicklung von chronischen Schmerzen in diesen Bereichen.
Überlastung durch Fehlbelastung
Fehlbelastungen im Fuß können sich auch direkt auf das Kniegelenk auswirken. Wenn ein Fuß aufgrund einer Fehlstellung oder Verletzung nicht richtig auf dem Boden aufsetzt, muss das Knie zusätzliche Stabilität und Anpassungsfähigkeit leisten. Dies kann zu Überlastung und Schmerzen im Knie führen, da es seine natürliche Biomechanik anpassen muss, um den Fehlwinkel des Fußes zu kompensieren.
Ein weiteres häufiges Problem ist die Überlastung des Sprunggelenks. Wenn der Fuß falsch abrollt oder das Körpergewicht nicht gleichmäßig verteilt wird, kann das Sprunggelenk überbeansprucht werden, was zu Schmerzen, Entzündungen oder sogar Verletzungen führen kann. Dies betrifft insbesondere Sportler oder Menschen, die viel stehen oder gehen müssen.
Vor allem im Vorfußbereich kommt es durch Fehlstellungen, zum Beispiel Hallux Valgus, oder Arthrosen (Gelenkverschleiß,
ßige Belastung auf den Fuß und die Gelenke zu verteilen. Sie können insbesondere bei Fehlstellungen wie Plattoder Hohlfuß helfen.
Die Behandlung von Fuß-, Knie- und Sprunggelenkschmerzen hängt von der jeweiligen Ursache ab. Eine genaue Diagnose durch einen Arzt oder Orthopäden ist entscheidend. Häufig kommen Maßnahmen wie Schuheinlagen, Muskeltraining und Innervationsschulung oder auch selten eine operative Korrektur der Fußstellung zum Einsatz.
1. Muskeltrainung: Gezielte Übungen können helfen, die Muskulatur im Fuß, Sprunggelenk und Knie zu stärken und Fehlbelastungen zu korrigieren. Eine richtige Fußgymnastik kann die Beweglichkeit und Stabilität der Gelenke verbessern und die Schmerzen lindern.
2. Schuheinlagen: Individuell angepasste Einlagen können helfen, Fehlstellungen zu korrigieren und eine gleichmä-
3. Magnetfeldtherapie und Stosswellenrherapie: Am Übergang zwischen Sehnen und Knochen, zum Beispiel Achillessehne (z B. Achillodynie) und Fersenbein (Fersensporn) kann es zu Reizzuständen und Entzündungen kommen. Beide Verfahren dienen zur Entzündungshemmung und führen über eine gesteigerte Stoffwechselaktivität und Zellregeneration zur Ausheilung der Beschwerden.
4. Chirurgische Eingriffe: Bei schwerwiegenden Fehlstellungen oder chronischen Verletzungen kann in seltenen Fällen eine Operation erforderlich sein, um das Gelenk zu stabilisieren oder eine Fehlstellung zu korrigieren.
Fazit
Fußprobleme sind häufig eine unterschätzte Ursache für Schmerzen im Knie und Sprunggelenk. Durch die enge Verbindung dieser Gelenke kann eine Fehlstellung oder eine Überlastung im Fußbereich zu langwierigen Beschwerden in

Fersensporn
den benachbarten Gelenken führen. Es ist wichtig, frühzeitig auf Anzeichen von Fehlbelastungen oder Schmerzen zu achten und gegebenenfalls medizinische Hilfe in Anspruch zu nehmen. Mit einer frühzeitigen Diagnose und geeigneten Therapien können die Beschwerden effektiv behandelt und langfristige Schäden vermieden werden.
Neben einer gründlichen ärztlichen Untersuchung führen weitergehende Maßnahmen wie zum Beispiel Röntgen oder eine dynamische Laufbandanalyse zur einer zielgerichteten Therapie. Unsere Praxis ist spezialisiert auf die Behandlung von Fuß-, Sprunggelenk-, Knie- und Hüftbeschwerden. Wir führen sämtliche anerkannten und bewährten Maßnahmen sowohl konservativ als auch operativ in diesen Bereichen durch. www.dr-fecher.de



Die BAG Radiologie & Nuklearmedizin Aschaffenburg freut sich, in Zusammenarbeit mit der Raiys GmbH aus Aschaffenburg ein modernes Online-ServiceAngebot einzuführen, das unsere Patientenversorgung erheblich verbessern wird.
Ab April können Patienten ihre Überweisungsscheine oder Rezepte und frühere Untersuchungsberichte bequem online hochladen. Dies reduziert den administrativen Aufwand für das Personal erheblich und stellt sicher, dass alle notwendigen Informationen für die Bildgebung vorliegen. Zusätzlich haben Patienten die Möglichkeit, in Ruhe zu Hause, digitale Fragebögen auszufüllen, um ihre Beschwerden genau zu schildern. Dies optimiert nicht nur die Planung der Untersuchungen, sondern auch die Qualität der Diagnosen.

Ein zentraler Vorteil ist die Verbesserung der Datenqualität: Durch die präzise und umfassende digitale Datenerfassung werden Fehler minimiert, Abläufe in der Praxis vereinfacht und die Diagnosen präziser. Für die Patienten bedeutet dies eine optimierte Untersuchungserfahrung mit weniger Verzögerungen und erhöhter Zufriedenheit. Die sichere DSGVOkonforme Verwaltung der Patientendaten gewährleistet zudem, dass sensible Informationen jederzeit geschützt sind.

Prof. Stephan Schmitz erklärt: „Für die bestmögliche Auswertung der Bilder brauchen Radiologen je nach Körperregion und Fragestellung sehr bestimmte Informationen, z B. wo und wie stark Schmerzen auftreten, ob ein Jugendlicher einen Unfall hatte, ob eine Patientin bereits eine Krebserkrankung durchgemacht hat, oder ob ein Knie schon einmal operiert wurde. Für eine optimale Planung der Untersuchungen hat man diese Informationen idealerweise schon am Tag vor dem Untersuchungstermin. Um Lösungen für diese Probleme zu entwickeln, habe ich 2022 die Raiys GmbH gegründet. Gemeinsam mit einem fantastischen Team aus Software-Entwicklern haben wir die Online-Anamnese entwickelt, die uns nun hilft, diese Informationslücken zu schließen und unsere Diagnosen sowie die Patientenversorgung erheblich zu verbessern.“
„Durch die Einführung dieser neuen Technologie bieten wir unseren Patienten nicht
nur mehr Flexibilität, sondern leisten auch einen wichtigen Beitrag zur Verbesserung der medizinischen Versorgung in der Region“, erklärt Dr. Zimmermann
Auch der Komfort der Patienten wurde deutlich verbessert. Durch die Möglichkeit, viele Formalitäten vorab online zu erledigen, können lange Wartezeiten in der Praxis reduziert werden. Dies kommt insbesondere Patienten zugute, die unter Zeitdruck stehen oder längere Anfahrtswege haben.
„Mit dieser Kooperation setzen wir einen weiteren Meilenstein für die Digitalisierung in der Radiologie am Bayerischen Untermain“, so die Radiologen der BAG abschließend. „Wir freuen uns, diese neue Technologie aktiv für unsere Patienten einsetzen zu können und gleichzeitig unser Engagement für moderne, patientenorientierte Lösungen zu bekräftigen.“




HIER FINDEN SIE UNS:
BAG Radiologie & Nuklearmedizin
Prof. Dr. med. Stephan Schmitz
Dr. med. Stefan Zimmermann
Hr. Wladimir Plastowez
Dr. med. Alexander Sauer & Kollegen
Frohsinnstraße 20 63739 ASCHAFFENBURG
Telefon 0 60 21/15 07 90
Spezialdiagnostik 0 60 21/1 50 79 99
Ausgelagerter Praxisteil Klinikum
Aschaffenburg-Alzenau
Am Schlosshof 1 63755 ALZENAU-WASSERLOS
Filialpraxis Seligenstadt
Mittelbeune 3 63500 SELIGENSTADT

Wir bieten ein umfangreiches Angebot an strukturierten, zertifizierten Schulungsprogrammen für alle Diabetesformen und Therapien an, ebenso wie „Auffrischungskurse“ und Online-Seminare zu speziellen Themen. Natürlich gibt es im Rahmen der Schulung auch praktische Veranstaltungen wie zum Beispiel Kochkurse. Die Schulungen finden in Kleingruppen vor Ort in einer stressfreien, angenehmen Atmosphäre statt. Die Leitung der Kurse erfolgt ausschließlich durch unser qualifiziertes und sehr erfahrenes Schulungsteam. Die Kosten für die Kurse und das Schulungsmaterial werden in der Regel von den Krankenkassen komplett übernommen. Weitere Informationen erhalten Sie über unsere Website und per E-Mail (siehe Kontakt).
DR. STEFANIE SCHRAMM
Fachärztin für Innere Medizin, Diabetologin DDG (Foto Mitte)





Bei uns immer in guten Händen.
Diabetes bedarf professioneller Hilfe. Sonst kann es zu Schädigungen an den Augen (Retinopathie), Nieren (Nephropathie) und Nerven (Neuropathie) kommen. Auch das Risiko für Herzinfarkt, Schlaganfall und Amputationen steigt stark an. Der Diabetes mellitus Typ 1 wird vorwiegend im Kindes- undJugendalter entdeckt und erfordert eine sofortige Insulinbehandlung. Der Typ 2 Diabetes ist oft Folge einer ungesunden Lebensweise und geht meist mit Bluthochdruck und Fettstoffwechselstörungen einher. Eine Sonderform stellt der Diabetes während der Schwangerschaft (Gestationsdiabetes) dar. Früherkennung und rechtzeitigeBehandlung spielen eine zentrale Rolle zum Wohl von Mutter und Kind.
Diabetes bedarf professioneller Hilfe. Sonst kann es zu Schädigungen an den Augen (Retinopathie), Nieren (Nephropathie) und Nerven (Neuropathie) kommen. Auch das Risiko für Herzinfarkt, Schlaganfall und Amputationen steigt stark an. Der Diabetes mellitus Typ 1 wird vorwiegend im Kindes- undJugendalter entdeckt und erfordert eine sofortige Insulinbehandlung. Der Typ 2 Diabetes ist oft Folge einer ungesunden Lebensweise und geht meist mit Bluthochdruck und Fettstoffwechselstörungen einher. Eine Sonderform stellt der Diabetes während der Schwangerschaft (Gestationsdiabetes) dar. Früherkennung und rechtzeitigeBehandlung spielen eine zentrale Rolle zum Wohl von Mutter und Kind.
Diabetes bedarf professioneller Hilfe. Sonst kann es zu Schädigungen an den Augen (Retinopathie), Nieren (Nephropathie) und Nerven (Neuropathie) kommen. Auch das Risiko für Herzinfarkt, Schlaganfall und Amputationen steigt stark an. Der Diabetes mellitus Typ 1 wird vorwiegend im Kindes- undJugendalter entdeckt und erfordert eine sofortige Insulinbehandlung. Der Typ 2 Diabetes ist oft Folge einer ungesunden Lebensweise und geht meist mit Bluthochdruck und Fettstoffwechselstörungen einher. Eine Sonderform stellt der Diabetes während der Schwangerschaft (Gestationsdiabetes) dar. Früherkennung und rechtzeitigeBehandlung spielen eine zentrale Rolle zum Wohl von Mutter und Kind.
AUSGEZEICHNETE SCHULUNGEN
Wir sind entsprechend den Richtlinien der Deutschen Diabetes Gesellschaft (DDG) als Behandlungs- und Schulungszentrum für Typ 1- und Typ 2 zertifiziert. Qualitätssicherung und die Zufriedenheit unserer Patientinnen und Patienten, steht für uns an erster Stelle.

ZENTRAL GELEGEN. HERVORRAGEND ERREICHBAR. Sie finden unsere moderne Praxis in direkter Nähe von Haupt- und Busbahnhof. Mit dem Auto parken Sie am einfachsten im Parkhaus am Hauptbahnhof. Von dort erreichen Sie die Praxis trockenen Fußes. Ein Aufzug bringt Sie bequem in den 6. Stock – unser Team um Dr. Inga- Nadine Kummer (im Foto links in der Mitte) heißt Sie herzlich willkommen.

ZENTRAL GELEGEN. HERVORRAGEND ERREICHBAR. Sie finden unsere moderne Praxis in direkter Nähe von Haupt- und Busbahnhof. Mit dem Auto parken Sie am einfachsten im Parkhaus am Hauptbahnhof. Von dort erreichen Sie die Praxis trockenen Fußes. Ein Aufzug bringt Sie bequem in den 6. Stock – unser Team um Dr. Inga- Nadine Kummer (im Foto links in der Mitte) heißt Sie herzlich willkommen.

ZENTRAL GELEGEN. HERVORRAGEND ERREICHBAR. Sie finden unsere moderne Praxis in direkter Nähe von Haupt- und Busbahnhof. Mit dem Auto parken Sie am einfachsten im Parkhaus am Hauptbahnhof. Von dort erreichen Sie die Praxis trockenen Fußes. Ein Aufzug bringt Sie bequem in den 6. Stock – unser Team um Dr. Inga- Nadine Kummer (im Foto links in der Mitte) heißt Sie herzlich willkommen.
Kontakt:
Kontakt:
Kontakt:
Elisenstraße
Elisenstraße 28
63739 Aschaffenburg



Telefon 06021 34 27 0
Telefax 06021 34 27
Elisenstraße 28 63739 Aschaffenburg Telefon 06021 34 27 0 Telefax 06021 34 27 20
Mail: info@fi-ab.de www.fachinternisten-aschaffenburg.de
Mail: info@fi-ab.de www.fachinternisten-aschaffenburg.de
Mail: info@fi-ab.de www.fachinternisten-aschaffenburg.de
In einer Welt, die sich immer schneller dreht, ist eine bewusste Ernährung mehr als nur ein Trend – sie ist der Schlüssel zu Gesundheit, Fitness und einem jungen, vitalen Erscheinungsbild. Menschen, die auf eine ausgewogene Ernährung achten, setzen nicht nur auf körperliche Gesundheit, sondern auch auf ihr äußeres Wohlbefinden. Und dazu gehören auch gerade, gesunde Zähne.
Ein gesunder Biss und gerade Zähne spielen eine entscheidende Rolle in diesem Zusammenspiel. Fehlstellungen können nicht nur die Zahngesundheit beeinträchtigen, sondern auch die Verdauung, da die Nahrung nicht optimal zerkleinert wird. Zudem kann eine ungünstige Kieferstellung zu Verspannungen im Nacken- und Kopfbereich führen. Durch eine kieferorthopädische Behandlung lassen sich nicht nur die Ästhetik, sondern auch die Funktion und damit das gesamte Wohlbefinden verbessern.
Gesunde Ernährung beeinflusst nicht nur unseren Stoffwechsel und unsere Zellgesundheit, sondern auch unseren gesamten Auftritt. Ein Mensch, der sich ausgewogen ernährt, wirkt oft vitaler, präsenter und jugendlicher. Die Versorgung des Körpers mit essenziellen Nährstoffen fördert die Regeneration und kann den Alterungsprozess verlangsamen. Ein gesunder Lebensstil unterstützt zudem die geistige Leistungsfähigkeit, das Immunsystem und das emotionale Wohlbefinden.
Ein gesundes Lächeln ist dabei ein sichtbares Zeichen innerer und äußerer Balance. Menschen, die auf ihre Ernährung achten, tun dies oft nicht nur für ihre Gesundheit, sondern auch für ihr Erscheinungsbild. Sie strahlen Vitalität, Energie und Selbstbewusstsein aus. Wer bewusst mit seinem Körper umgeht, investiert in seine Zukunft und zeigt, dass Gesundheit, Schönheit und ein harmonischer Biss Hand in Hand gehen.

Unsere moderne Lebensweise stellt hohe Anforderungen an unseren Körper. Stress, mangelnde Bewegung und unregelmäßige Mahlzeiten können sich negativ auf das allgemeine Wohlbefinden auswirken. Wer bewusst auf eine gesunde Ernährung setzt, schenkt seinem Körper die Energie
und Vitalstoffe, die er braucht, um leistungsfähig, ausgeglichen und vital zu bleiben. Diese bewusste Lebensweise zeigt sich nicht nur in einer besseren körperlichen Gesundheit, sondern auch in einem strahlenden Hautbild, einer frischen Ausstrahlung und einer positiven Grundstimmung.

Gesunde Ernährung ist weit mehr als eine Modeerscheinung – sie ist eine Lebenseinstellung. Sie fördert nicht nur das allgemeine Wohlbefinden, sondern auch die innere und äußerliche Ausstrahlung. Gerade, gesunde Zähne unterstützen nicht nur eine bessere Kaufunktion und Verdauung, sondern tragen auch zu einem vitalen, selbstbewussten Auftreten bei. Wer sich bewusst ernährt und auf seine Zahn- und Kiefergesundheit achtet, lebt gesünder, fühlt sich wohler und strahlt dies auch aus. Ein strahlendes Lächeln ist nicht nur ein Zeichen von Attraktivität, sondern auch von innerem Wohlbefinden.
Vorübergehend hier: Frohsinnstr. 17 63739 Aschaffenburg 06021.440700
fritzwatzlaw.de
Autoimmunerkrankungen sind eine Gruppe von Erkrankungen, bei denen das Immunsystem im Rahmen einer Fehlregulation und Überaktivität körpereigene Zellen und gesunde Gewebe angreift. Zu den bekanntesten gehören Multiple Sklerose (MS), rheumatoide Arthritis (RA), Typ1-Diabetes und chronisch entzündliche Darmerkrankungen (IBD) wie Colitis ulcerosa und Morbus Crohn. Die Ursachen dieser Erkrankungen sind komplex und beinhalten genetische Prädispositionen, Umwelteinflüsse und immunmodulatorische Faktoren. Unsere Ernährung hat als Umweltfaktor das Potenzial, die Krankheitsentwicklung und den Verlauf von Autoimmunerkrankungen zu beeinflussen.

1. Ernährung bei Autoimmunerkrankungen im Allgemeinen
Die Deutsche Gesellschaft für Ernährung (DGE) betont, dass eine ausgewogene, abwechslungsreiche Ernährung als Grundlage für die Gesundheit dient und bei Autoimmunerkrankungen von besonderer Bedeutung ist. Eine ausgewogene Ernährung trägt zur Modulation des Immunsystems bei, kann entzündliche Prozesse dämpfen und das Risiko für Komorbiditäten wie HerzKreislauf-Erkrankungen und Diabetes minimieren, die bei Patienten mit Autoimmunerkrankungen häufig vorkommen. Der DGEErnährungskreis empfiehlt eine Ernährung, die reich an Obst, Gemüse, Vollkornprodukten, Ballaststoffen, fettarmen Milchprodukten und hochwertigem Eiweiß ist. Insbesondere sollen
entzündungsfördernde Lebensmittel wie gesättigte Fette und Zucker sowie Schweinefleisch nur in Maßen konsumiert werden, was nicht bedeutet, dass vollständig auf sie verzichtet werden soll. Zudem wird eine ausreichende Zufuhr von essentiellen Fettsäuren empfohlen, insbesondere Omega-3-Fettsäuren und kurzkettigen Fettsäuren, da sie entzündungshemmende Eigenschaften besitzen. Bei Autoimmunerkrankungen des rheumatischen Formenkreises und chronisch entzündlichen Darmerkrankungen wird auf die Bedeutung von Antioxidantien und Mikronährstoffen wie Vitamin C und Vitamin E hingewiesen, die im Körper sogenannte freie Radikale, meist Sauerstoffspezies, binden. Geeignet ist eine mediterrane Kost und ovo-lactovegetarische Ernährung. Zur Verringerung der Zufuhr entzündungsfördernder Arachidonsäure ist eine Begrenzung des Ver-
zehrs von Schweinefleisch sinnvoll. Langkettige, mehrfach ungesättigte Fettsäuren (EPA und DHA) können über ein bis zwei Fischmahlzeiten pro Woche zugeführt oder in Form von Fischölkapseln verabreicht werden.
Multiple Sklerose ist eine chronische entzündliche Erkrankung des zentralen Nervensystems, bei der es zu fokaler und diffuser Schädigung der Myelinscheiden und Nervenfasern kommt. In den letzten Jahren wurde zunehmend untersucht, inwiefern Ernährung den Verlauf der MS beeinflussen kann. Die Deutsche Multiple Sklerose Gesellschaft (DMSG) empfiehlt eine ausgewogene Ernährung im Sinne einer „mediterranen Kost“, eine Vermeidung hochkalorischer Kost sowie die Reduktion von Übergewicht und den Verzicht auf Rauchen. Besonderes Augenmerk wird auf Vitamin D, Omega-3-Fettsäuren und sekundäre Pflanzenstoffen gelegt. Spezielle, oft in Laienforen propagierte Diäten wie die “Keto-Diät” oder die “Paläo-Diät” haben bislang keine gesicherten Ergebnisse zur Verbesserung des Krankheitsverlaufs bei MS gezeigt.
Vitamin D: Ein niedriger Vitamin-D3-Spiegel wird mit einem höheren Risiko für das Auftreten und den Verlauf von MS in Verbindung gebracht. Eine ausreichende Zufuhr von Vitamin D durch Sonnenlichtexposition und gegebenenfalls Nahrungsergänzungsmittel ist daher von Bedeutung. Die DGN empfiehlt eine tägliche Zufuhr von 80 0 –1000 IE Vitamin D für Erwachsene, wobei Patienten mit MS eventuell eine höhere Dosis benötigen, maximal jedoch 20.000 IE pro Woche. Es sollte ein Vitamin D3-Spiegel von 30 ng/ml oder höher erreicht werden. Höhere Spiegel als 80 ng/ml, wie sie bei chronischer Überdosierung und insbesondere bei dem sog. Coimbra-Protokoll auftreten können, sind dagegen schädlich und können zu Krämpfen, Unruhe und sogar zu einer Verschlechterung der Autoimmunprozesse führen.
Omega-3-Fettsäuren: Sie können entzündungshemmend und neuroprotektiv wirken und möglicherweise das Risiko für Krankheitsschübe reduzieren können. Sie sind vor allem in fetthaltigen Fischarten wie Lachs, Makrele und Hering sowie in pflanzlichen Quellen wie Leinsamen und Walnüsse enthalten und sollten regelmäßig in die Ernährung integriert werden. Eine bevorzugte Aufnahme von Seefisch auf den Speiseplan ein- bis zweimal pro Woche ist hierzu meist ausreichend und obendrein schmackhaft. Lediglich bei vegetarischer Ernährung sollten die o.g. Fettsäuren in Form von Fischölkapseln und auch Vitamin B12 zusätzlich zugeführt werden.
Antioxidantien: Sekundäre Pflanzenstoffe, wie sie in rotem Obst, Wein und Gemüse vorkommen, haben das Potenzial, die Entzündungsreaktionen im Körper zu verringern und oxidative Schäden zu vermeiden. Daher wird empfohlen, fünfmal am Tag zu Obst und Gemüse zu greifen.
Olivenöl: Natives, d.h. nicht raffiniertes oder extrahiertes Olivenöl aus erster Kaltpressung (meist bezeichnet als „virgen extra“ oder „extra vergine“) ist ein zentraler Bestandteil der mediterranen Ernährung und zeichnet sich durch einen hohen Gehalt an einfach ungesättigten Fettsäuren sowie antioxidativen Polyphenolen aus. Beobachtungen aus Mittelmeerländern legen nahe, dass der regelmäßige Verzehr von nativem Olivenöl ent
Mit wissenschaftlicher Expertise und fachärztlicher Kompetenz kümmern wir uns mit unserem erfahrenen Team aus drei Fachärzten für Neurologie sowie medizinischen Fachangestellten als zertifiziertes Schwerpunktzentrum für Multiple Sklerose und Parkinson um Ihre Gesundheit, was Erkrankungen des zentralen und peripheren Nervensystems und der Muskeln betrifft. Langjährig etabliert, bietet die Gemeinschaftspraxis mit ihrer neuen Ärztegeneration eine neue Philosophie mit moderner Diagnose und Therapie in Verbindung mit Sorgfalt und zeitgemäßer Organisationsstruktur. Insbesondere das neue OnlineTerminbuchungssystem reduziert Wartezeiten.
Unser Ärzteteam:



Unser Diagnostik- und Behandlungsspektrum in der Neurologie:
n Duplexsonographie
n Klinische Neurophysiologie
n Liquordiagnostik
n Infusionstherapie
n Botulinumtoxin-Therapie bei Bewegungsstörungen
n Studienzentrum neue Therapien
Unsere Schwerpunkte und Spezialitäten:
n Multiple Sklerose (DMSG)
n Parkinson-Erkrankungen
n Neuromuskuläre Erkrankungen und Neuropathien
n Bewegungsstörungen und Dystonien
n Migräne
n hATTR-Amyloidose
Stadtpalais Elisenstraße 32 Eingang B

zündungshemmende Effekte hat, die für Patienten mit chronischen Autoimmunerkrankungen vorteilhaft sein können. Polyphenole stammen dabei aus der Olivenschale und machen den charakteristischen leicht bitteren adstringierenden Geschmack besonders hochwertiger Olivenöle mit niedrigem Säuregehalt (< 0,3%) aus.
Milch und Milchprodukte: Prinzipiell ist Kuhmilch ein gesundes Lebensmittel. Sie enthält wertvolles Calcium, Vitamine und Mineralstoffe. Die DGE empfiehlt daher, täglich Milch oder Milchprodukte zu sich zu nehmen. Möglicherweise gilt dies aber nicht uneingeschränkt für MS-Patienten. Einige Betroffene klagen nach dem Konsum von Milch, Quark, Käse oder Joghurt über eine Verschlechterung ihrer Symptome, ähnlich wie bei Wärme, Fieber und Infekten. Grundlagenwissenschaftliche Forschungen an der Universität Bonn konnten zeigen, dass manche MS-Betroffene, aber auch Gesunde, eine Allergie gegen ein Kuhmilcheiweiß, nämlich Casein haben. In ihrem Serum finden sich Antikörper gegen Casein, die in der Zellkultur mit einem Oberflächenantigen der Markscheiden der Nervenfasern (myelin-associated glycoprotein, MAG) kreuzreagieren. Umgekehrt können Antikörper gegen MOG (myelin oligodendrocyte glycoprotein), die bei ca. einem Drittel von MS-Patienten vorkommen können und oft in einem Mausmodell der MS (EAE) verwendet werden, mit einem Kuhmilcheiweiß namens Butyrophilin kreuzreagieren. Diese Antikörper und MAG-reaktive B-Zellen können dann zu einer Schädigung von Nervengewebe in Hirn und Rückenmark führen. Möglicherweise ist ein höherer Milchkonsum ein ähnlicher aber deutlich weniger relevanter Risikofaktor für die Entstehung von Multipler Sklerose in bestimmten Bevölkerungsgruppen, wie die Infektion mit EbsteinBarr-Virus (EBV) eine unbedingte Voraussetzung dafür ist. Umgekehrt entwickelt aber nicht jeder Mensch mit Milcheiweißallergie oder EBV eine MS, dazu sind noch viele weitere Veranlagungsfaktoren nötig. Testen auf das Vorhandensein von Casein-Antikörpern kann man in der Routine noch nicht.
Ein weiterer wichtiger Aspekt ist der Einfluss von Ernährung auf das Mikrobiom im Darm, das bei Autoimmunerkrankungen eine bedeutende Rolle spielt. Die Förderung einer gesunden Darmflora durch Prä- und Probiotika könnte das Immunsystem positiv beeinflussen und die Symptome bei Autoimmunerkrankungen lindern. Hierbei spielen kurzkettige Fettsäuren wie die Propionsäure und Buttersäure eine besondere Rolle. Propion-
säure ist nicht in der Nahrung enthalten, sondern entsteht erst im Darm durch die Fermentation von Ballaststoffen durch spezifische Darmbakterien, deren Anwesenheit im Mikrobiom mit einem günstigen Krankheitsverlauf und weniger Schüben assoziiert ist. Hierbei scheint Propionsäure die Anzahl und Funktion regulatorischer T-Zellen zu erhöhen, die eine Schlüsselrolle bei der Kontrolle autoimmuner Entzündungen spielen. Dagegen verringert Propionsäure die Zahl an entzündungsfördernden h1- und Th17-Helfer-Zellen. Mehrere grundlagenwissenschaftliche Beobachtungen ergaben, dass bei (v.a. unbehandelten) MS-Patienten das Darmmikrobiom verändert ist zugunsten entzündungsfördernder, wenig Propionsäure produzierender Spezies. Eine proof-of-concept-Studie an der Ruhr-Universität Bochum, an ca. 300 MS-Patienten konnte zeigen, dass die orale Gabe von Propionsäure bei MS-Patienten die Schubrate senkte und das Fortschreiten der Behinderung verlangsamte. Diese Ergebnisse unterstreichen das Potenzial von Propionsäure als ergänzende Therapie bei MS und möglicherweise auch bei anderen Autoimmunerkrankungen.
Bei der Behandlung von Autoimmunerkrankungen (insbesondere der Multiplen Sklerose) kommt der personalisierten Auswahl und dem konsequenten Einsatz geeigneter immunmodulatorischer oder auch immunsuppressiver Therapien eine besonders grundlegende Bedeutung zu. Diese muss an die individuelle und aktuelle Aktivität der Erkrankung und die Vorgeschichte uns Lebensplanung angepasst und regelmäßig überwacht und deren Effektivität kontrolliert werden. Nur damit ist ein günstiger Verlauf auf viele Jahre hinaus zu gewährleisten, Schübe und Behinderungsprogression zu vermeiden und Lebensqualität zu erhalten. Die Ernährung spielt eine bedeutende Rolle im unterstützenden Management von Autoimmunerkrankungen und kann durch eine gezielte Modulation des Immunsystems sowie durch die Förderung einer gesunden Mikrobiota den Verlauf von Erkrankungen wie Multiple Sklerose, rheumatoider Arthritis und anderen Autoimmunerkrankungen positiv beeinflussen. Eine besondere Bedeutung kommt hierbei einer ausgewogenen mediterranen ballaststoffreichen und kalorienarmen Ernährung zu, die reich an entzündungshemmenden Nährstoffen wie Omega-3-Fettsäuren, Vitamin D und Antioxidantien ist. Weitere klinische Studien sind jedoch erforderlich, um diese Effekte zu bestätigen und spezifische Ernährungsempfehlungen geben zu können. Ihr Arzt und Ihre Ärztin beraten sie gerne.
Literatur beim Verfasser Dr. Jochen C. Ulzheimer
Stadtpalais | Elisenstraße 32 | Eingang B 63739 Aschaffenburg Telefon 0 60 21/44 98 60 | Telefax 0 60 21/44 98 62 44 info@neuropraxis-ab.de
aus dem Frauenärzte Gesundheitszentrum Aschaffenburg

Seit dem 01.10.2024 konnten wir eine weitere Fachärztin für unser Frauenärzte Gesundheitszentrum Aschaffenburg gewinnen. Frau Tâmara Camargos Jensen ist Fachärztin für Frauenheilkunde und Ge burtshilfe und war bis 30.09.2024 im Klinikum Aschaffenburg tätig.
Wir freuen uns sehr, dass Frau Tâmara Camargos Jensen ein Teil des Ärzteteams ist und sagen noch einmal herzlich willkommen!
Besuchen Sie uns gerne auch unter fagz.de
Ihr Frauenärzte Gesundheitszentrum Dr. Henze & Kolleginnen



Weil das Leben immer einen Grund findet, sich zu feiern.

Sie haben den Anlass, wir haben jede Menge Spaß im Glas. Ob mit oder ohne — mit unserem Sortiment bleibt kein Auge trocken.


…erfrischt anders!

In den letzten Jahren etabliert sich die pflanzenbasierte Ernährung zunehmend in unserer Gesellschaft. Immer mehr Menschen entscheiden sich dafür, ihre Ernährung auf pflanzliche Lebensmittel umzustellen, sei es aus gesundheitlichen Gründen oder aufgrund des steigenden Bewusstseins für die Umwelt. Doch was steckt genau hinter einer pflanzenbasierten Ernährung, und welche Vorteile

Das ist eine wirklich schöne Frage zum Einstieg. Da es noch zeitig am Morgen ist, während ich die Fragen beantworte, habe ich bisher tatsächlich nur gefrühstückt. Ohne ein Frühstück mag ich nur ungern in den Tag starten. Mein gewohntes Frühstück sieht dabei sehr „klassisch“ aus: Es gibt zwei Scheiben Roggenvollkornbrot von einer Aschaffenburger Familien-Bäckerei, dazu etwas Natur-Frischkäse und meist süßen Brotaufstrich. Heute war es ein selbstgemachter Trauben-Gelee, den ich von einer Patientin geschenkt bekommen habe.
Können Sie uns erklären, was unter einer pflanzenbasierten Ernährung verstanden wird?
Bisher gibt es für diese Ernährungsweise noch keine einheitliche, wissenschaftliche Definition. Wie die Bezeichnung aber ganz klar erkennen lässt, handelt es sich um eine Essensweise, bei der – überwiegend bis ausschließlich – pflanzliche Lebens-
tierungshilfe können die Empfehlungen der sogenannten „Planetary Health Diet“ der EAT-Lancet-Kommission sein. Hierbei handelt es sich um Empfehlungen zur Verzehrsmenge verschiedener Lebensmittelgruppen, die sowohl für die menschliche als auch die planetare Gesundheit als verträglich gelten. Auch die Deutsche Gesellschaft für Ernährung DGE hat im März 2024 ihre Empfehlungen „Gut essen und trinken“ überarbeitet, wodurch nochmal stärker als bisher diverse pflanzliche Nahrungsmittel in den Fokus gerückt wurden. Insgesamt geht es bei einer pflanzenbasierten Ernährung ganz klar darum, weniger tierische Lebensmittel zu verzehren.
mit Verboten noch mit Verzicht ist das zu erreichen. Achtet man auf einen möglichst großen Anteil von Gemüse und Obst, Vollkorngetreide, Hülsenfrüchten sowie Nüssen und pflanzlichen Ölen auf dem eigenen Teller, nimmt man auf diesem Weg viele lebensnotwendige und gesundheitsförderliche Nährstoffe, wie beispielsweise Ballaststoffe, Vitamine, Mineralstoffe sowie sekundäre Pflanzenstoffe und ungesättigte Fettsäuren zu sich. Gleichzeitig wird durch das Reduzieren tierischer Lebensmittel die Aufnahme von Kalorien, gesättigten Fettsäuren und Cholesterin gesenkt. So kann diese Ernährungsweise dazu beitragen, dass Risiko für Übergewicht, Herz-Kreislauf-Erkrankungen und auch Typ-2-Diabetes zu senken. Auch der sparsame Einsatz von hochverarbeiteten Lebensmitteln sollte dazu beachtet werden.

Retten wir die Welt, wenn wir mehr pflanzlich essen?
Ist eine pflanzenbetonte Ernährung besser für die Gesundheit als andere Ernährungsformen?
Theoretisch ja. Voraussetzung ist, dass das entscheidende Grund-Prinzip dabei immer lauten sollte: „Ausgewogen, von allem etwas, aber eben alles in der richtigen Menge“. Weder
Kann diese Ernährungsform helfen, Krankheiten zu heilen?
„Heilung“ ist in der Medizin ein wirklich großes Wort. Man versteht darunter die Rückbildung, also das Verschwinden von einer Erkrankung. Ob die pflanzenbasierte Ernährung das schaffen kann, ist wissenschaftlich noch nicht abschließend erforscht bzw. bestätigt. Diese Ernährungsform kann sicherlich helfen, die Wahrscheinlichkeit, bestimmte Erkrankungen zu bekommen, zu senken. Und allein das wäre in meinen Augen ein mehr als lohnenswertes Argument für diese Essensweise. Mit dem Begriff„Heilung“ wäre ich in diesem Zusammenhang dennoch vorsichtig.
Ist sie Alltagstauglich?
Absolut. Wir haben heute ein unfassbar großes LebensmittelAngebot im Bereich der pflanzlichen Produkte und auch was mögliche Ersatzprodukte angeht. Und ständig kommen Neue mit dazu. Natürlich sollte man genau schauen, ob die pflanzlichen Ersatzprodukte wirklich immer die bessere und gesündere Alternative zum „tierischen Original“ sind, aber auf diesem Markt hat sich in den letzten Jahren vieles getan. Im Mittelpunkt einer pflanzenbasierten Ernährung stehen vor allem die Lebensmittel, die uns die Natur selbst liefert, wie Gemüse, Salat, Obst und dergleichen. Kochbücher, Ratgeber und Rezept-Datenbanken im Internet sind voll mit tollen und leckeren Ideen, wie es uns gelingen kann, mehr pflanzliche Produkte auf unsere Teller zu bringen! Auch in unseren Diabetes-Kursen bieten wir hierzu immer Anregungen und Tipps an.
Gibt es Risiken, was muss man beachten?
Sofern man auf eine ausgewogene Auswahl aller Lebensmittelgruppen achtet und sich an den genannten Empfehlungen der DGE orientiert, wird es nicht zu gesundheitlichen Risiken kommen. Entscheiden sich Menschen für eine vegane Ernährung und somit für den Verzicht auf tierische Nahrungsmittel, gibt es einige Dinge zu beachten. Am Besten informiert man sich im Vorfeld intensiv und holt sich Unterstützung durch eine ausgewiesene, zertifizierte Ernährungsfachkraft, die auf diesem Gebiet spezialisiert ist. Je nach Alter und körperlicher Verfassung (z B. Schwangerschaft, Stillzeit) ist bei rein veganer Ernährungsweise die Einnahme von bestimmten Supplementen dringend angeraten, um etwaigen Risiken bestmöglich vorbeugen zu können.
Als Ernährungsfachkraft fände ich es natürlich wunderbar, wenn sich alleine durch eine geeignete Ernährungsform die Welt retten ließe. Realistisch ist dieser Wunsch sicherlich nicht. Dazu ist das aktuelle Weltgeschehen wohl viel zu komplex. Nachgewiesen ist aber an mehreren Stellen ganz klar und deutlich: Je mehr pflanzliche und desto weniger tierische Lebensmittel weltweit gegessen werden, desto mehr senken wir den globalen Wasserverbrauch und CO2-Ausstoß, es wäre mehr im Sinne von Tierschutz getan und die Ernährung der gesamten Weltbevölkerung ließe sich leichter sicherstellen. Auf individueller Ebene handeln wir letztendlich mehr im Sinne unsere eigene Gesundheit. Ob wir die Welt dadurch wirklich retten können, bleibt abzuwarten. Aber wir können sie dadurch sicherlich ein ordentliches Stück besser und fairer gestalten!

Veronika Köberlein
Diabetesberaterin DDG
Staatlich Geprüfte Diätassistentin
09/97 – 05/06: Maria-Ward-Gymnasium, Aschaffenburg –Abschluss Hochschulreife/Abitur
09/06 – 07/09: Staatliche Berufsfachschule für Diätassistenten an der Universität Würzburg –Ausbildung zur staatlich geprüften Diätassistentin
Ab 01/10: Diabetes-Schulungszentrum von Dr. Martine und Dr. Gerhard Klausmann
03/11 – 03/12: erfolgreiche Weiterbildung am Diabeteszentrum des Universitätsklinikums der Friedrich-Schiller-Universität in Jena vom zur Diabetesberaterin DDG
Ab 01/20: Gemeinschaftspraxis Dr. G. Klausmann & Dr. S. Schirmmacher- Memmel
– Umbenennung wegen Gesellschafterwechsel (s.u.) –
Seit 07/21: Fachinternisten Aschaffenburg
Praxis Dr. I. Kummer & Dr. S. Schirmmacher-Memmel

Unser AED speichert im Notfall alle Daten ab, wir können den gesamten Verlauf sofort an die behandelnden Ärzte weitergeben, in kürzester Zeit steht unsere Auswertung zur Verfügung. Dazu müssen einige Mitstreiter das Gerät zum Hersteller einsenden, absolut zeitlos.
Nachbarschaft geht auch so:
Ein beherzter Bürger ergriff In Obernau die Initiative und mobilisierte seine Nachbarn, etwas für die Sicherheit zu investieren. Ein paar Spenden und eine großzügige Unterstützung durch die Regierung von Unterfranken haben es ermöglicht, einen AED an der Hauswand in der Bahnhofstraße zu installieren. Jederzeit für alle zugänglich.
Plötzliches Herzversagen kann jeden treffen, ob im Sportverein, am Arbeitsplatz oder im öffentlichen Raum. In solchen Situationen zählt jede Sekunde. Ein AED (Automatisierter Externer Defibrillator) kann Leben retten, durch gezielte Stromstöße das Herz wieder in den richtigen Rhythmus bringen. Mit dieser Initiative setzt Hubrich Medical ein starkes Zeichen für Sicherheit und Gesundheitsvorsorge in unserer Region. Und jeder kann das Gerät bedienen. Den Sekundentod verhindern, das hat sich unser Unternehmen auf die Fahne geschrieben.

Verlosung an zwei Sportvereine
Nicht zum ersten Mal wurden zwei funkelnagelneue AEDs an Sportvereine verlost. In diesem Jahr hießen die glücklichen Gewinner SG Wasserrettung aus Aschaffenburg und die Fußballer des SV Richelbach. Die feierliche Übergabe fand bereits im Februar in unseren Räumlichkeiten statt. Gemeinsam mit dem Oberbürgermeister der Stadt Aschaffenburg Jürgen Herzing überreichte die Geschäftsleitung die Geräte. Für weitere fünf Vereine gab es Trostpreise, je eine gute befüllte Notfalltasche.

Die AEDs sind mit neuester Technik ausrüstet, die ständige Überwachung der Gerätefunktionen und des Standorts per App sind hier bereits verbaut. Denn es gibt bei den installierten Rettern immer wieder technische Probleme, zwar angeschafft aber ohne weitere Wartung, im Notfall ein Fauxpass. Daher dürfen ab 2027 nur noch Geräte mit GPS in Verkehr gebracht werden.


Jederzeit informiert: Die App zum AED. (Foto: Nihon Kohden)

Unsere Kunden
Zahlreiche Vereine, Sportstätten, Behörden und Unternehmen. Die Stadt Aschaffenburg, viele Feuerwehren, die Firmen Suffel Fördertechnik, Kaup und Dressler Bau, Linde MH, um nur einige zu nennen. Vielen Dank an diese Unternehmen, die sich die Sicherheit Ihrer Mitarbeiter etwas kosten lassen.
Kauf, Miete, Leasing und kurzfristiger kostenloser Verleih
Den einzigen Fehler, den Du mit einem AED machen kannst ist, ihn im Notfall nicht zu benutzen.
Diesen Leitsatz hat sich unser Seniorchef vor Jahren auf die Fahne geschrieben, seitdem wurden mehrere hundert Installationen vorgenommen. Und es ist richtig: Durch den Einsatz kann weder der Retter noch der Patient zu Schaden kommen.


Es gibt viele Möglichkeiten, einen Lebensretter zu installieren. Sprechen Sie uns einfach an. Für kurze Events stellen wir interessierten Vereinen ein Gerät kostenlos zur Verfügung, ohne Gebühren, vielleicht eine kleine Spende an den Verein „AED rettet Leben“ in Aschaffenburg. Von dort wurden bereits zahlreiche Installationen unterstützt.
Ob wir diese Aktion wiederholen?
Die Verlosung hat uns sehr viel Spaß gemacht, auch unseren Mitarbeitern, die gerne an der Sache mitgewirkt haben. Dafür ein herzliches Dankeschön. Wir haben viel Zustimmung erhalten und weiteres Interesse geweckt. Es wird sicher weitere Aktionen geben.
Ein Beitrag von Markus Prößler, Rettungssanitäter und Medizinprodukteberater im Fachbereich Medizintechnik bei Hubrich Medical. :00 Uhr, Vermessungstermine jederzeit nach Vereinbarung – auch zuhause










Fachgeschäft mit Tradition und Innovation: Versorgung bei hubrich medical seit 1952. hubrich medical ist seit über 70 Jahren eine feste Größe in Aschaffenburg. Rund 35 Mitarbeiter:innen machen sich täglich stark für die Gesundheitsversorgung „ihrer“ Patient:innen, für mehr Mobilität und Lebensqualität. Für die Anproben aller Bandagen stehen wir Ihnen zu den untenstehenden Ladenöffnungszeiten gerne zur Verfügung. Für das Vermessen von Flachstrickkompression oder Brustprothetik bitten wir um telefonische Terminvereinbarung, wir wollen für Ihre Beratung genügend Zeit einplanen. Gerne können sie uns Ihr Rezept vorab per WhatsApp, E-Mail oder Fax zusenden, wir setzen uns mit Ihnen umgehend in Verbindung.

Außerdem stehen Ihnen spezialisierte Fachangestellte auch für folgende Fachbereiche mit Beratung zur Verfügung: Badewannenlifter, Bandagen, Brustprothetik, Defibrillatoren, Homecare, Inkontinenzartikel, Kompressionsstrumpfversorgung, Patientenlifter, Pflegehilfsmittel, Rollatoren, Rollstühle, Orthesen, Schienen, Sauerstofftherapie, Therapierollstühle, Toilettenstühle, Treppensteiger, Treppenlifte.
Magnolienweg 8, 63741 AB-Nilkheim
Die Internationale Kunstmesse MAIN ART feiert 2025 ihr 10-jähriges Jubiläum und präsentiert sich im Zeichen der künstlerischen und kulturellen Vielfalt.

Die 6. Internationale Kunstmesse MAIN ART blickt auf eine beeindruckende Dekade zurück. Als sich die Messe 2015 zum ersten Mal der Öffentlichkeit präsentierte, damals noch in Erlenbach am Main, war sie für die Besucher neu und unbekannt. Heute ist die Internationale Kunstmesse als bedeutende Plattform für zeitgenössische Kunst in Aschaffenburg und darüber hinaus etabliert. Die Organisatorinnen Brigitte Seiler-Rothfuss und Rita Stern bringen jedes Mal aufs Neue zahlreiche Künstler, Galerien sowie Kunstliebhaber zusammen und schaffen einen Raum, in dem sowohl kreative Ideen als auch innovative Werke präsentiert werden können.
Vom 17. bis 18. Mai 2025 wird die 1904 erbaute Grünewaldhalle im Herzen Aschaffenburgs erneut Kulisse für zeitgenössische Kunst in all ihren Formen, die Kunstliebhaber, Sammler, Galeristen und Künstler zusammenbringt und daraus Verbindungen zwischen Menschen und Kulturen schafft. Das Besondere der dargebotenen, erstaunlichen Vielfalt: Regionale Künstler präsentieren sich neben international Etablierten und somit wird der grenzübergreifende Austausch angeregt. Die Organisatorinnen legen wie auch schon in den Vorjahren Wert darauf, Nachwuchstalenten eine Plattform zu bieten und ihnen somit eine nachhaltige Etablierung am Kunstmarkt zu ermöglichen.
Kuratorin Bianca Hambusch (Kunsthistorikerin, Mannheim), die seit Anfang an dabei ist, sinniert mit Freude über die gemeinsamen Jahre: „Die Main Art verbinde ich mit Liebe zur Kunst: hier darf man Mensch sein, den eigenen Gefühlen und Instinkten vertrauen, authentisch und selbstbewusst sein, Entspannung genießen und Kraft tanken – Kunstschaffende wie Kunstliebende gleichermaßen. Ich freue mich auf zehn Jahre Main Art Community: for artlovers!“
Vielfalt und Reichtum der internationalen Kunstszene fördern
Gemeinsam mit den Kuratorinnen Elisabeth Claus (Neuer Kunstverein Aschaffenburg) und Iris Solbès (KunstLanding Aschaffenburg) ist es Bianca Hambusch gelungen, eine künstlerische wie auch kulturelle Vielfalt an qualitativ hochwertigen Kunstwerken aller Genres zu treffen: 49 Kunstschaffende aus 12 Nationen, darunter 8 Nachwuchskünstler, 5 Künstlervereinigungen und eine Galerie. Geboten werden Kunstwerke aus allen Bereichen –von den klassischen Genres Malerei, Zeichnung, Grafik, Skulptur und Fotografie über Collagen, Assemblage, Cut Out, filigrane Papierkunst oder Mixed Media bis hin zur Computergrafik, die anhand einer Augmented Reality „live“ erlebt werden kann.
„Als Kuratorin bin ich stolz darauf, dass auf der MAIN ART die Vielfalt und der Reichtum der internationalen Kunstszene gefördert werden. Ich freue mich auf inspirierende Begegnungen und Würdigung der Kunstschaffenden, indem Kunstwerke von Kunstliebenden erworben werden.“ so Hambusch.
Nähe zum Menschen
Begegnungen vor Ort lassen einen gesellschaftlichen Zusammenhalt entstehen. Dazu zählen kostenlose Führungen für Schüler sowie Erwachsene und der individuelle, intensive Austausch mit den Ausstellern, die sich unter einander optimal vernetzen und an After Art Abenden austauschen können.
Eine gewollte Interaktion mit den Besuchern zeigt sich auch im Voting und der Verleihung des jährlichen Publikumspreises – dotiert mit 1.000 € Der Besucher hat die Möglichkeit, in die Welt aller Künstler einzutauchen, einen Blick hinter die Kulissen der individuellen Arbeit eines Künstlers zu werfen und durch intensive Gespräche zu einem Teil des künstlerischen Prozesses zu werden. Die sehr übersichtliche Messestruktur macht es den Besuchern einfach, sich bei der breiten Diversität an künstlerischen Positionen zu orientieren.
Die Organisatorinnen Seiler-Rothfuss und Stern freuen sich über die hervorragende Zusammenarbeit mit der Stadt Aschaffenburg und danken allen Partnern und Kulturförderern, die eine derartige Veranstaltung überhaupt erst möglich machen.
Die MAIN ART wurde 2015 in Erlenbach am Main erstmalig eröffnet und präsentierte der Öffentlichkeit eine vielfältige Schau zeitgenössischer Kunstwerke von rund 90 Künstlern aus 11 Nationen. Um die Messe nach dem Erfolg in 2015 zentraler erreichbar zu machen, zog die MAIN ART ab 2017 nach Aschaffenburg. Hier präsentierten sich 2017 im Aschaffenburger Schloss Johannisburg rund 40 Künstler aus 6 Nationen, seit 2022 in der Grünewaldhalle 45 Künstler aus 9 Nationen, 2023 50 Künstler aus 12 Nationen und 2024 46 Künstler aus 13 Nationen. 2025 präsentieren sich 49 Kunstschaffende aus 12 Nationen, darunter 8 Nachwuchskünstler, 5 Künstlervereinigungen und eine Galerie. Die Künstler wurden durch das Kuratorinnenteam, bestehend aus Bianca Hambusch, Elisabeth Claus und Iris Solbès, zugelassen. Geboten werden Kunstwerke aus allen Bereichen – von den klassischen Genres Malerei, Zeichnung, Grafik, Skulptur und Fotografie über Collagen, Assemblage, Cut Out, filigrane Papierkunst oder Mixed Media bis hin zur Computergrafik, die anhand einer Augmented Reality „live“ erlebt werden kann. Veranstalter: MAIN ART GbR.
Die MAIN ART 2025 findet vom 17 bis 18 Mai in der GRÜNEWALDHALLE, Grünewaldstr. 12 63739 Aschaffenburg statt. Eintritt: 8,– EUR / Ermäßigter Eintritt: 6,– EUR (Kinder in fam. Begleitung bis 13 Jahre frei).
Führungen durch die Kuratorin: 60 Min. / kostenlos.

APOTHEKE
07 (GLEIS EINS, S. 26/27)
Bahnhof-Apotheke
Dr. Tobias Craan e.K.
Ludwigstraße 2 (am Hauptbahnhof)
63739 ASCHAFFENBURG
Telefon 0 60 21/39 89 0
Telefax 0 60 21/39 89 15
info@bahnhof-apotheke.biz www.bahnhof-apotheke.biz
AUGENKLINIK
08 (GLEIS EINS, S. 32/33)
ReVis Augenzentren
Dr. med. Natascha Lipka
Dr. med. Thomas Kasper
Wan-Azlan Wan-Omar
Dr. med. Marieta Kalcheva
Dr. med. Andreas Fischle
Dr. med. Joachim Puchta
Dr. med. Martin Lambert Aleksandr Berezin
Stadtpalais Elisenstraße 32 (Eingang A + B) 63739 ASCHAFFENBURG
Facharztpraxis
Ludwigstraße 2 63739 ASCHAFFENBURG
OP und Augen Laser Zentrum
Frohsinnstraße 29 63739 ASCHAFFENBURG
Facharztpraxis
„Notfallsprechstunde“ und „Sehschule (Kinder)“
Telefon 0 60 21/44 98 70
Am Sägewerk 10 63773 GOLDBACH
ReViS Augenzentrum Spessart MVZ
Telefon 0 60 21/55 02 08
Bezirksstraße 30 63755 ALZENAU-WASSERLOS Facharztpraxis
Telefon 0 60 23/50 70 50
Erlenbacher Straße 16 63820 ELSENFELD
Facharztpraxis
Telefon 0 60 22/65 19 90
Breitendieler Straße 32 63897 MILTENBERG
OP Zentrum und Facharztpraxis
Telefon 0 93 71/65 03 00
Hauptstraße 10 74731 WALLDÜRN
Facharztpraxis
Telefon 0 62 82/60 08
www.revis.de
FRAUENÄRZTE
10 (GLEIS EINS, S. 20/21)
Frauenärzte Gesundheitszentrum
Aschaffenburg
Dr. med. Alexander Henze & Kolleginnen
Magnolienweg 12 63741 ASCHAFFENBURG
Telefon 0 60 21/4 44 77 30
Telefax 0 60 21/4 44 77 333
www.fagz.de
INNERE MEDIZIN
09 (GLEIS EINS, S. 40/41)
Fachinternisten Aschaffenburg Praxis
Dr. Kummer & Dr. Schirrmacher-Memmel
Dr. Inga-Nadine Kummer
Fachärztin für Innere Medizin, Diabetologie, Ernährungsmedzin und Notfallmedizin
Dr. Silke Schirrmacher-Memmel
Fachärztin für Innere Medizin, Hämatologie und internistische Onkologie, Palliativmedizin
Dr. Stefanie Schramm
Fachärztin für Innere Medizin
Manjola Lushi
Weiterbildungsässistentin Hämatologie/Onkologie
Dr. Ariane Brogsitter
Fachärztin für Innere Medizin, Hämatologie und int. Onkologie, Palliativmedizin
MUDr. Zuzana Miklasová Fachärztin für Innere Medizin und Gastroenterologie
Elisenpalais | Elisenstraße 28 63739 ASCHAFFENBURG
Telefon 0 60 21/34 27-0
info@fi-ab.de
www.fachinternisten-aschaffenburg.de
08 (GLEIS EINS, S. 28/29)
Gastroenterologische Gemeinschaftspraxis Aschaffenburg
Priv.-Doz. Dr. med. Hardi Lührs
Priv.-Doz. Dr. med. Ralph Melcher
Prof. Dr. med. Wolfgang Fischbach
Dr. med. Karl Metz
Dr. med. Caroline Noé
Dr. med. Oliver Tabarelli
Stadtpalais Elisenstraße 32 (Eingang B) 63739 ASCHAFFENBURG
Telefon 0 60 21/44 47 80 Telefax 0 60 21/44 47 850
praxis@gastro-ab.de www.gastro-ab.de
KARDIOLOGIE + INNERE MEDIZIN
08 (GLEIS EINS, S. 22/23)
Kardiologische Gemeinschaftspraxis Aschaffenburg
Dr. med. Andreas Görz
Priv.-Doz. Dr. med. Werner Peters
Fachärzte für Innere Medizin und Kardiologie
Hypertensiologie DHL® Sportmedizin
Stadtpalais Elisenstraße 32 (Eingang A) 63739 ASCHAFFENBURG
Telefon 0 60 21/3 86 72 -0
Telefax 0 60 21/3 86 72 25
www.kardiologie-ab.de
KIEFERORTHOPÄDIE
05 (GLEIS EINS, S. 42/43)
Fritz Watzlaw Kieferorthopädie Fritz Watzlaw
Fachzahnarzt für Kieferorthopädie
Dr. Sarah Watzlaw
Angestellte Zahnärztin
Ludwigstraße 15 63739 ASCHAFFENBURG
Telefon 0 60 21/44 07 00
www.fritzwatzlaw.de
Vorübergehende Adresse: Frohsinnstraße 17, 63739 ASCHAFFENBURG
NEUROLOGIE
08 (GLEIS EINS, S. 44/45)
Neuropraxis im Stadtpalais Gemeinschaftspraxis für Neurologie, DMSG-Schwerpunktpraxis Multiple Sklerose
Dr. med. Jochen C. Ulzheimer Facharzt für Neurologie, Botulinumtoxintherapie (DGN), Schwerpunkt Neuroimmunologie/ Multiple Sklerose
Priv.-Doz. Dr. med. Carsten Wessig Facharzt für Neurologie, Spezielle Neurologische Intensivmedizin, Verkehrsmedizin, Schwerpunkt Neuromuskuläre Erkrankungen
Dr. med. Jessica Herröder Fachärztin für Neurologie, Schwerpunkt neurodegenerative Erkrankungen/ Parkinson-Syndrome
Stadtpalais | Elisenstraße 32 (Eingang B) 63739 ASCHAFFENBURG
Telefon 0 60 21/44 98 60
Telefax 0 60 21/44 98 62 44
info@neuropraxis-ab.de www.neuropraxis-ab.de
ORTHOPÄDIE UND SPORTMEDIZIN
06 (GLEIS EINS, S. 36/37)
Praxis für Orthopädie und Sportmedizin
Dr. Klaus Fecher
Facharzt für Orthopädie, Sportmedizin, Schwerpunkt Fußchirurgie
Gregor Böhler
Facharzt für Unfallchirurgie und Orthopädie
Konsiliarärzte
in der Bergman Clinics, Hofgartenklinik, Aschaffenburg
Ludwigstraße 4
63739 ASCHAFFENBURG
Telefon 0 60 21/58 03 10 info@dr-fecher.de www.dr-fecher.de
AUGENOPTIK + HÖRAKUSTIK
04 (GLEIS EINS, S. 17)
SCHWIND SEHEN & HÖREN
63755 ALZENAU-WASSERLOS
Bezirksstraße 30
Telefon 0 60 23/9 18 97 32
63739 ASCHAFFENBURG
Frohsinnstraße 32
Telefon 0 60 21/44 87 90
63808 HAIBACH
Hauptstraße 5
Telefon 0 60 21/6 30 90
63768 HÖSBACH
Hauptstraße 7
Telefon 0 60 21/54 05 48
63801 KLEINOSTHEIM
Goethestraße 58 a
Telefon 0 60 27/65 44
63897 MILTENBERG
Hauptstraße 136
Telefon 0 93 71/76 50
Hörakustik-Filiale
63897 MILTENBERG
Hauptstraße 44
Telefon 0 93 71/94 96 61
63785 OBERNBURG
Römerstraße 57
Telefon 0 60 22 14 85
63500 SELIGENSTADT
Bahnhofstraße 6
Telefon 0 61 82/82 94 30
www.schwind-sehen-hoeren.de
PHYSIOTHERAPIE/FITNESS/ KOSMETIK & FUSSPFLEGE
09 (GLEIS EINS, S. 24/25)
Praxis für ganzheitliche Gesundheitspflege
Christine Schwarz
Elisenpalais | Elisenstraße 28 63739 ASCHAFFENBURG
Telefon 0 60 21/1 21 84
Telefax 0 60 21/45 71 71
www.krankengymnastik-schwarz.de
RADIOLOGIE UND NUKLEARMEDIZIN
02 (GLEIS EINS, S. 38/39)
Prof. Dr. Stephan Schmitz und Kollegen
BAG Radiologie und Nuklearmedizin
Frohsinnstraße 20 63739 ASCHAFFENBURG
Telefon 0 60 21/15 07 90
Privathotline 0 60 21/1 50 79 99 www.radiologie-ab.de
SPRACHTHERAPIE
03 (GLEIS EINS, S. 16 + 30/31)
Akademische Praxis für Sprachtherapie
Dr. phil. Ingeborg Maser
Neurolinguistin/Klinische Linguistin dbs/dbl
Frohsinnstraße 28 63739 ASCHAFFENBURG
Telefon 0 60 21/45 27 27
Telefax 0 60 21/45 27 28
www.sprachtherapie-maser.de
UROLOGIE
06 (GLEIS EINS, S. 18/19)
Dr. med. Patrick Sawaya Facharzt für Urologie
Ludwigstraße 4 63739 ASCHAFFENBURG
Telefon 0 60 21/1 33 55
Telefax 0 60 21 21 90 01
www.dr-sawaya.de
Nilkheim
Magnolienweg

ZAHNÄRZTE
01 (GLEIS EINS, S. 34/35)
Gemeinschaftspraxis Prof. Dres. Kreusser, Hechler & Kollegen
Prof. Dr. Dr. Bernd Kreusser Facharzt für Mund-, Kiefer- und Gesichtschirurgie
Spezialist für Implantologie
Dr. Joachim Kreusser Fachzahnarzt für Oralchirurgie
Spezialist für Implantologie und Ästhetische Zahnheilkunde
Dr. Manfred Hechler Facharzt für Mund-, Kiefer und Gesichtschirurgie
Plastische Operationen
Tätigkeitsschwerpunkt Implantologie
Dr. Sabine Hechler Zahnärztin
Tätigkeitsschwerpunkt Ästhetische Zahnheilkunde
Dr. Florian Kreusser Zahnarzt
Belegärzte in der Hofgartenklinik und im Klinikum Aschaffenburg Friedrichstraße 19 63739 ASCHAFFENBURG
Telefon 0 60 21/35 35 0
Telefax 0 60 21/35 35 35
www.kreusser-hechler.de




Frohsinnstr. 28 03





